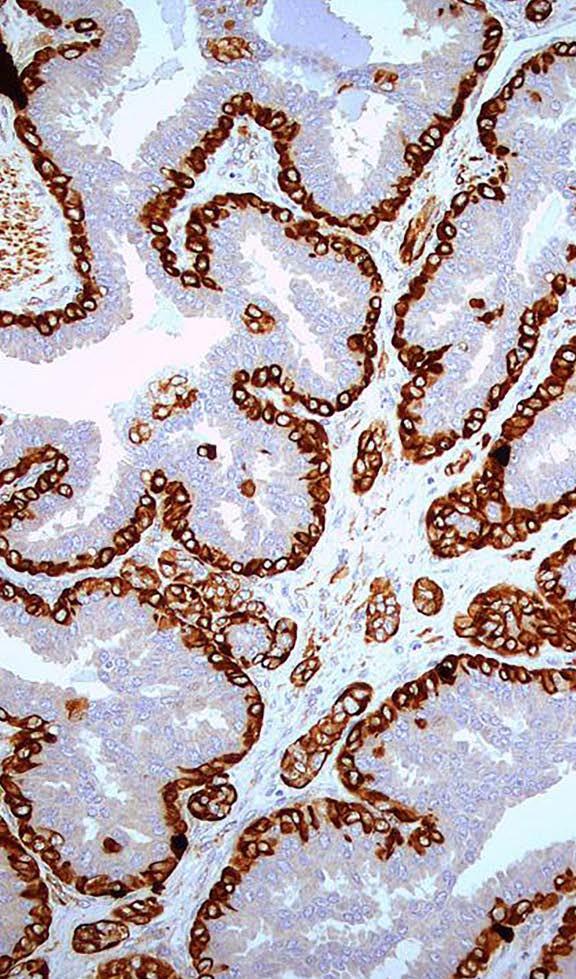

![]()






En esta edición especial de nuestra revista, nos embarcamos en una mirada profunda y multidisciplinaria al tema del cáncer, una de las amenazas en material de salud más complejas y persistentes de nuestra era. Por primera vez, dedicamos la totalidad de nuestras páginas a una sola temática, lo cual no es casualidad: el cáncer es, sin duda, uno de los grandes desafíos médicos, sociales y económicos del siglo XXI.
Cada año, el mundo es testigo de más de 20 millones de nuevos diagnósticos de cáncer y cerca de 10 millones de muertes atribuibles a esta enfermedad, según estimaciones de la OMS. El cáncer ya no es una condición limitada al envejecimiento o a los países de altos ingresos. Su incidencia crece rápidamente en países pobres, donde los sistemas de salud aún luchan por ofrecer diagnóstico temprano, acceso a medicamentos esenciales y atención integral.
La carga económica del cáncer es importante: se estima en más de 1.16 billones de dólares anuales, entre costos directos en salud y pérdidas por productividad. Para las familias, especialmente en países emergentes, el diagnóstico de cáncer puede representar una catástrofe financiera. El impacto no se mide solo en terapias o cirugías, sino en ahorros agotados, ingresos perdidos, y decisiones devastadoras como abandonar el tratamiento por falta de recursos.
El psiquiatra Héctor Pérez nos muestra en su excelente articulo “El impacto emocional en las personas del diagnóstico de Cáncer” el tortuoso camino por el que viajan el paciente y sus familiares en este difícil proceso.
En la República Dominicana, el cáncer también impone una carga sanitaria creciente. Con cerca de 18,000 casos nuevos por año y una mortalidad cercana a los 10,000 fallecimientos anuales, se ha convertido en una prioridad de salud pública. La infraestructura oncológica ha mejorado notablemente en la última década, con instituciones como el INCART, el IORC, y el fortalecimiento de la red pública de medicamentos de alto costo. Sin embargo, los desafíos persisten: inequidades en el acceso, diagnósticos tardíos, y la necesidad urgente de más inversión en prevención y registros poblacionales confiables.
Este año, se han destinado miles de millones de pesos dominicanos al tratamiento del cáncer en el sistema de salud. Pero el impacto va más allá del Estado: afecta a las familias, los empleadores y la economía nacional. El cáncer golpea el tejido social, exige solidaridad médica y responsabilidad institucional.
La esperanza no es lejana. La medicina personalizada, la inmunoterapia, el uso de inteligencia artificial en diagnóstico, y los avances en genómica tumoral están transformando la manera en que entendemos y tratamos el cáncer. La prevención, a través de vacunas como la del VPH, campañas de estilo de vida saludable y detección temprana, sigue siendo la herramienta más poderosa. Hay mucho por hacer todavía, en nuestro país el 65% de los canceres de mama se diagnostican en etapas avanzadas. La Dra. Esthenia García, oncóloga, nos muestra en su artículo “El arte de la individualidad en el tratamiento oncológico: Personalización en los nuevos tiempos” hacia done se dirige la investigación actual para el tratamiento del cáncer.
Pero el futuro también exige liderazgo, cooperación intersectorial, y una mirada ética: ¿cómo aseguramos que estos avances lleguen también a los más vulnerables? ¿Qué papel juegan las políticas públicas en garantizar el acceso equitativo?
Esta edición especial busca aportar conocimiento, reflexión y propuestas. Más de veinte médicos especialistas de nuestra torre han contribuido con artículos de alto nivel científico, cubriendo desde los cánceres más prevalentes hasta los avances terapéuticos más recientes.
Nunca más agradecidos con nuestros patrocinadores que se han solidarizado con el tema tratado en esta edición y como siempre nos han apoyado para poder hacer realidad nuestra publicación.
Que estas páginas no solo informen, sino que inspiren acción, colaboración y compromiso.
Porque el cáncer no es solo un diagnóstico médico: es un llamado urgente a la ciencia, a la política, a la humanidad.
Editor: Dr. José de Jesús
Coordinadora editorial: Nijshme Mascaró
Coordinador de diseño editorial: Guillermo Vásquez
Diseñadores: Estefany Ramírez Guillermo Vásquez
Guillermo Silva Siara Belén
Diseño de portada: Guillermo Vásquez info@docmedia.do (809) 862-0935 www.docmedia.do
Imprenta: Amigos del Hogar Sto. Dgo., República Dominicana

Dr. José de Jesús de Jesús Editor

El melanoma ocular es un tipo poco común pero serio de cáncer que se forma en las células que dan color al ojo, llamadas melanocitos. Aunque es mucho más raro que el melanoma de piel es el tumor maligno más frecuente que se origina dentro del ojo en los adultos. La mayoría de los casos ocurren en una parte del ojo llamada úvea, que incluye el iris, el cuerpo ciliar y la coroides.
¿Qué lo causa?
Todavía no se conoce con exactitud qué causa el melanoma ocular, pero se han identificado algunos factores de riesgo. Es más común en personas de piel y ojos claros, y generalmente ocurre después de los 50 años. A diferencia del melanoma de piel, la exposición al sol no parece tener un papel importante en su desarrollo.
También se han encontrado mutaciones genéticas específicas en estos tumores que ayudan a predecir su comportamiento y agresividad.
¿Cuáles son los síntomas?
En muchos casos, el melanoma ocular no produce síntomas en sus etapas iniciales y puede descubrirse por casualidad durante un examen rutinario de la vista. Cuando aparecen síntomas, pueden incluir visión borrosa, destellos de luz, manchas oscuras en

el campo visual o una mancha visible en el iris. En ocasiones, si el tumor es grande o afecta el drenaje del ojo, puede causar dolor o aumento de la presión ocular.
¿Cómo se diagnostica?
El diagnóstico se realiza principalmente con un examen oftalmológico detallado.
El especialista puede observar el interior del ojo con instrumentos especiales y realizar estudios como ecografía ocular o fotografías del fondo del ojo. En la mayoría de los casos no es necesario hacer una biopsia, ya que las características del tumor suelen ser muy evidentes.
¿Es peligroso?
El melanoma ocular puede crecer localmente dentro del ojo, pero su
principal peligro es que puede hacer metástasis, es decir, diseminarse a otras partes del cuerpo. El lugar más común al que se disemina es el hígado. Aproximadamente la mitad de los pacientes con melanoma ocular desarrollan metástasis en algún momento de su vida, a veces muchos años después del tratamiento inicial.

¿Cómo se trata?
El tratamiento depende del tamaño, la localización del tumor y el estado general del paciente.

Las opciones incluyen:
Observación: En casos muy pequeños o dudosos, el médico puede optar por vigilar el tumor antes de intervenir.
• Radioterapia localizada: Es el tratamiento más común y consiste en colocar una pequeña placa con material radiactivo directamente sobre el ojo para atacar el tumor. Esto permite conservar el ojo en la mayoría de los casos.
• Cirugía: En algunos casos, es necesario extirpar el tumor o incluso el ojo completo (enucleación) si el tumor es muy grande o no se puede controlar de otra manera.
• Terapias nuevas: Cuando el cáncer se ha diseminado, el tratamiento se vuelve más difícil. Sin embargo, recientemente han surgido nuevas opciones como la inmunoterapia o medicamentos dirigidos que están ofreciendo algo de esperanza para mejorar la supervivencia en casos avanzados.
¿Qué pasa después del tratamiento?
Después del tratamiento local, es fundamental hacer un seguimiento regular, ya que el riesgo de metástasis persiste. Se recomienda realizar estudios del hígado cada 6 o 12 meses para detectar cualquier señal de diseminación temprana. Esto puede

incluir análisis de sangre y estudios de imágenes como ecografías o resonancias magnéticas.
¿Se puede prevenir?
No existe una forma clara de prevenir el melanoma ocular, pero hacerse chequeos oftalmológicos regulares puede ayudar a detectarlo en etapas más tempranas, cuando es más tratable. También es importante prestar atención a cualquier cambio en la visión o en la apariencia del ojo y consultar al oftalmólogo ante cualquier síntoma sospechoso.
En resumen
El melanoma ocular es un cáncer poco frecuente pero potencialmente grave.Su detección temprana y tratamiento adecuado pueden marcar una gran diferencia en el pronóstico. Gracias a los avances médicos, hoy en día es posible conservar el ojo en muchos casos y se están desarrollando terapias cada vez más efectivas para combatir su forma metastásica. Si tienes factores de riesgo o notas algo inusual en tu visión, no dudes en consultar a un médico oftalmólogo quien es especialista en esta materia.

Dr. Carlino González Gil
Director Médico
Unidad Oftalmológica Medical Net
El cérvix es la parte más baja del úteroylo comunica con la vagina.También se le conoce como cuello uterino. El cáncer de cérvix ocurre cuando las células del cuello uterino se tornan anormalesycrecen descontroladamente.
Hay dos tipos principales de cáncer cervical, el carcinoma escamoso y el adenocarcinoma, basado en la clase de células a partir de la cual se originan. En la gran mayoría de los casos el cáncer de cérvix es causado por el virus del Papilloma Humano (VPH).
Las pruebas de tamizaje pueden identificar cáncer y precáncer de cérvix en sus etapas iniciales cuando aún responde a tratamiento, y de ese modo disminuyen el número de personas afectadas por cáncer cervical así como la cantidad de muertes causadas por esta patología.
¿Qué prueba de tamizaje se aconseja realizar?
Existen diversas modalidades de tamizaje para cáncer cervical: el Papanicolaou o citología, la prueba de VPH y la combinanción de ambas pruebas. Hoy en día estamos presenciando un cambio de paradigma
en lo que respecta a las pruebas de tamizaje para cáncer cervical, ya que la mayoría de las instituciones que se consideran autoridades en la materia están recomendando la prueba de VPH por encima del tradicional Papanicolaou que por varias décadas fue el gold standard.

¿A partir de qué edad se debe realizar la prueba de tamizaje y con qué frecuencia?
El cáncer cervical es extremedamente raro en personas jóvenes, sin importar a qué edad hayan comenzado a tener relaciones sexuales. La Organización Mundial de la Salud recomienda iniciar el tamizaje de cáncer de cérvix
a los 25 años de edad, mientras que el Colegio Americano de Obstetras Ginecólogos propone los 21 años como edad de inicio.
La mayoría de las infecciones por VPH que ocurren antes de los 21 años de edad son temporales y no se asocian a cáncer cervical. Si realizamos pruebas de tamizaje antes de la edad recomendada, podemos exponernos al riesgo del estigma que conlleva el sobrediagnóstico y el sobretratamiento con procedimientos que a futuro pueden traernos complicaciones al momento de querer tener hijos.
El intervalo de tiempo entre cada tamizaje depende del tipo de la prueba seleccionada. Con el Papanicolaou se recomienda repetir la prueba cada 3 años, mientras que con la prueba de VPH la recomendación es cada 5 años.
Es posible que tu ginecóloga te recomiende relizar la prueba con mayor frecuencia si tu sistema immune no funciona normalmente (si tomas un medicamento inmunosupresor, si eres VIH positiva, etc), si eres fumadora, si te expusiste a un medicamento que aumente tu riesgo de padecer cáncer cervical o si has tenido resultados anormales en el pasado. A veces también realizamos la prueba antes del intervalo recomendado basándonos en la calidad de la última muestra colectada
o en la calidad de la prueba a la que tenenos acceso en nuestro sistema de salud o porque así lo dictamina la cobertura del plan de salud de cada paciente.
También es importante recalcar que estas recomendaciones están diseñadas para pacientes que no tienen ningún síntoma. Si presentas manchado después del coito, si estás sangrando fuera de lo normal para tu ciclo menstrual o si tienes un flujo anormal, tu ginecóloga va a querer examinarte y probablemente te aconseje ponerte al día con la prueba de tamizaje para cáncer cervical. Este ejemplo permite resaltar por qué es crucial evitar los auto-tratamientos de síntomas ginecológicos. Usar óvulos vaginales sin antes ser examinada por un profesional médico o ignorar síntomas porque “todo salió bien” en una sonografía transvaginal autoindicada, puede dilatar el diagnóstico y el tratamiento adecuado de condiciones muy serias de salud como el cáncer cervical.
Además de realizarme la prueba de tamizaje con la frecuencia que recomiende mi médico, ¿qué más puedo hacer para disminuir mi riesgo de padecer cáncer cervical?
1.
Vacúnate contra el Virus del Papiloma Humano (VPH). Consulta con tu ginecóloga para saber si esta vacuna está recomendada en tu rango de edad. Las recomendaciones sobre la edad de vacunación, el número de dosis y las cepas virales incluidas en la vacuna, así como la cobertura por parte de los seguros médicos, se van actualizando de una manera muy dinámica. Aún cuando hayas tenido un Papanicolaou anormal o una prueba de VPH positiva, la vacuna puede protegerte.
2.
Evita el tabaquismo en todas sus modalidades (cigarrillo convencional y electrónico, tabaco, etc).
3.
Evita contagiarte con el virus de inmunodeficiencia humana (VIH). Si ya eres seropositiva, sigue tu tratamiento al pie de la letra.
¿Qué debo hacer si tengo un Papanicolaou anormal o una prueba de VPH positiva?
Lo primero que debes saber es que una prueba de tamizaje anormal o positiva NO significa que tienes cáncer. Significa que es necesario revisarte con más frecuencia o más profundamente, como por ejemplo con una colposcopía y una biopsia. Ponte en manos de profesionales de salud a quienes les tengas confianza y te acompañaremos en este proceso.



El diagnostico de Cáncer causa sentimiento profundo y multifacético que afecta a los pacientes no solo en su cuerpo sino también en su mente y sus emociones desde el proceso del diagnóstico hasta la remisión. Las personas con cáncer enfrentan altibajos emocionales que pueden persistir en el tiempo aún después de finalizado sus tratamientos.
La misma palabra cáncer impresiona a las personas por sus consecuencias no solo para el paciente afectado sino para los familiares y la comunidad. El término Cáncer es universal, la palabra cáncer proviene del idioma griego por su la similitud de la enfermedad con el animal crustáceo (cangrejo) debido a que a partir de una lesión tumoral se ramifica a otros órganos en el cuerpo; el cáncer es el crecimiento anormal y a veces acelerado de las células del órgano afectado.
Este artículo está basado en las observaciones del autor como psiquiatra que acompaña a pacientes con esta condición. Trataremos de explicar sobre el impacto emocional tanto para el paciente como para su entorno familiar y social; tomaremos en consideración nuestra apreciación del impacto de estos pacientes en el personal médico (doctores, enfermeras, terapeutas y el personal de apoyo en las unidades de Oncología).
¿Qué piensan las personas cuando oyen hablar de Cáncer?
Hay una extensa mezcla de sentimientos, principalmente “MIEDO y PREOCUPACION”. Ya que el cáncer está asociado a: dolor, sufrimiento, incertidumbre, enfermedad grave y costosa y peligro de muerte. La noticia es impactante y abrumadora dejando al paciente y a sus familiares perplejos y hasta con reacciones de enojo y sentimientos de culpabilidad, principalmente por lo que se pensó y no se hizo. Esta diversidad de pensamientos y sentimientos afectan directamente en la salud mental de las personas con manifestaciones inmediatas de ansiedad y depresión, estos síntomas no son únicamente del paciente, sino que llega a todos en su familia y relacionados. La dimensión de los síntomas es diferente de persona a persona y si el paciente padece de algún trastorno psiquiátrico previo al diagnóstico de cáncer, el riesgo de resurgimiento de los síntomas de la condición mental es potencialmente alto.
El estrés y la ansiedad se manifiestan de inmediato por la incertidumbre sobre el futuro, los tratamientos y sus posibles efectos secundarios y la posibilidad de que afecten la imagen corporal; en esta etapa todos
estos sentimientos son una repuesta normal a una situación anormal.
La evolución de estos pensamientos lleva a la manifestación de trastornos psiquiátricos siendo el más habitual la afección de ánimo “Depresión” cuyos síntomas influyen en la calidad de vida y el futuro de las personas, especialmente en los primeros días del diagnóstico y más aún si el pronóstico es grave o que necesiten tratamientos agresivos. Los estudios con relación a este periodo del diagnóstico de cáncer indican que el 85% de estos pacientes son de alto riesgo para cometer suicidio en comparación con la población general y en comparación con otras condiciones médicas delicadas. El riesgo va disminuyendo proporcionalmente para los pacientes candidatos a quimioterapia, y aún menor para los candidatos a radioterapia únicamente como modalidad de tratamiento esta proporción disminuye para los pacientes que son candidatos para cirugía con la expectativa de liberarse del cáncer.
Muchos pacientes inicialmente pueden resistirse a aceptar el diagnóstico, lo que llamamos psicológicamente “mecanismo de defensa: Estado de negación” y en consecuencias no aceptan las recomendaciones de tratamiento, empiezan a dudar de todos, especialmente de sus familiares y acompañantes además del personal médico; sus estado emocionales se hacen frágiles con cambios repentinos del estado de humor, poca tolerancia a las frustraciones, mucha ambigüedad en la toma de decisiones, desean la soledad y el aislamiento, afloran pensamientos intrusivos frecuentemente de negatividad y fatalistas todo en resumen: sufrimiento para estas personas.
En esta etapa la intervención de profesionales de la salud mental (psiquiatras, psicólogos, consejeros o coaching) son altamente necesarias con la finalidad de superar la crisis y de apoyo emocional; hay veces en que la situación ameritara el uso de psicofármacos para ayudar a mejorar el estado emocional de este paciente.

Mencionaremos brevemente el impacto psicológico en los cánceres ginecológicos en mujeres jóvenes los cuales además de los sentimientos descritos al momento hay un duelo inmediato por la perdida posible de la fertilidad, preocupaciones con la autoimagen, las relaciones de pareja y la sexualidad, los síntomas de depresión pueden aparecer como primera reacción en las jóvenes y con tendencias al aislamiento y mucho miedo por la posibilidad de procedimientos agresivos muchas veces quirúrgicos.

Factores que insiden en la manifestacion de trastornos del humor.
1. 2. 3. 4. 5. 6. 7. 8.
Historia familiar o herencia de trastornos del humor como: Depresión, Trastorno Bipolar, Ciclotimia, Depresión crónica o Distimia además de Ansiedad generalizada y estrés post traumático.
Previa historia de un trastorno psiquiátrico.
Influencia de los rasgos de personalidad del paciente.
Historia de traumas psicológicos.
Soledad, aislamiento social.
La falta de apoyo emocional.
Dificultades económicas.
La variedad del cáncer y el estadio clínico del mismo (tamaño del tumor, órganos afectados, metástasis, inflamación…).
Desde la sospecha de un cáncer en una persona, el periodo de análisis y estudios, citas médicas, hasta el diagnóstico son una carga emocional angustiante y sumamente estresante que aumenta la ansiedad afectando diferentes esferas psicológicas de las personas, desde su desenvolvimiento cotidiano, laboral, interpersonal, dificultad para descansar o dormir. Todo este efecto deja abierta las posibilidades de eventualmente desarrollar trastornos psiquiátricos, hay personas que aún los resultados sean favorablemente NEGATIVOS quedan con lo que llamamos “Síndrome del estrés postraumático” o con un trastorno “obsesivo compulsivo” con relación a su salud y su cuidado. También existe la posibilidad de que esos síntomas escalen a trastornos mentales mas complejos como depresión, psicosis, abuso de tanto de medicamentos, suplementos naturales con la idea de prevenir el cáncer y el uso de sustancias psicoactivas, alcohol, tabaco, etc.
Esta descrito que pacientes sin previo historial de un desorden de psiquiátrico puedan requerir temporalmente la intervención de profesionales de la salud mental. Igualmente existe la posibilidad de que personas con herencia de problemas mentales que nunca hayan tenido manifestaciones de ningún tipo debuten con síntomas de desordenes psiquiátricos.
La calidad de vida de los pacientes con cáncer que van desde limitaciones a incapacidad para sus actividades ordinarias, reducción de sus ingresos, perdida de empleos y la posibilidad de convertirse en una carga económica para sus familiares.
¿Que hay mas alla del paciente?

Los familiares pueden manifestar una amplia variedad de sentimientos en torno a su familiar con cáncer como: El miedo a perder un ser querido y afectivamente importante para el grupo familiar; ansiedad por no saber como cuidar a su familiar enfermo y la incertidumbre del desarrollo de los tratamientos, cambios en sus rutinas para acompañarlos a las citas del médico y durante los posibles internamientos, frustración e impotencia por no poder controlar las adversidades, es todo un “agotamiento emocional” que se puede complicar si el paciente se agrava , con una gran cuota de energía para el día a día de su familiar y la esperanza de una mejoría. Son frecuentes los conflictos entre los familiares por desacuerdos de cómo se están manejando las cosas y por los que sienten no ser reconocidos por sus esfuerzos en la situación. Hay un factor común entre los familiares y es el temor y el pesar del fallecimiento de un ser querido, hay ocasiones que estas preocupaciones producen un duelo anticipado en algunos familiares. Se ha observado que aún el paciente sobrepasa la situación hay quienes en la familia quedan con una cicatriz emocional particularmente si el proceso fue complicado, traumático o prolongado.

Los familiares más jóvenes (niños y adolescentes) sufren un periodo de confusión principalmente enfocados en, ¿quién será mi protector? mas que en la condición de salud del enfermo. Los adolescentes experimentan miedo y tristeza quizás porque empiezan a sentir la responsabilidad de cuidar un adulto enfermo y velar por los menores de la familia, este es un periodo de ajuste para ellos en donde la mezcla de sentimientos puede manifestarse con frustración y rebeldía.

¿Que pasa con los profesionales de la salud?

A los profesionales de la salud que tratan pacientes con cáncer los afecta no solo la demanda física y técnicas de los tratamientos; ellos tienen además un costo emocional que puede afectar su propio bienestar y la calidad de las atenciones que brindan.
La constancia de trabajar con pacientes que padecen enfermedades graves les puede generar un agotamiento emocional conocido como “Fatiga por compasión” donde se afecta la capacidad de empatizar y la desesperanza, esto surge del contacto frecuente con el sufrimiento ajeno.
El “Burnout” es otra manifestación del personal de salud: Es el desafío al agotamiento del médico dando la sensación de falta de realización personal, miedo de contraer y transmitir enfermedades e insatisfacción por el trabajo realizado
Conclusion:
El cáncer no solo afecta el cuerpo, sino también la mente y la emotividad del paciente. Estos efectos pueden magnificarse por factores como el estigma social, el aislamiento, agotamiento, los efectos secundarios de los tratamientos y la baja autoestima; sin embargo, el apoyo psicológico adecuado, la intervención temprana, la solidaridad de los que los apoyan, pueden mitigar significativamente estos efectos mejorando la capacidad del paciente para sobrellevar la enfermedad.
Es fundamental incluir el cuidado de la salud mental como parte integral del tratamiento oncológico y del equipo de trabajo. La comunicación efectiva y abierta entre el paciente, familiares y personal médico es fundamental para fomentar una experiencia positiva y esperanzadora durante el proceso.
La psicoterapia, los grupos de apoyo, las técnicas para el manejo del estrés y los psicofármacos han demostrado ser eficaces para reducir el impacto y las secuelas psicológicas en los pacientes con cáncer además del bienestar emocional, mejorando los resultados generales de los tratamientos.







Los tumores primarios del sistema nervioso central (SNC) son la segunda causa más común de cáncer en edad pediátrica, excedido en incidencia por las leucemias y constituyen aproximadamente un cuarto de todas las neoplasias en niños.
La incidencia para pacientes entre 0 y 19 años varia desde 3.3 a 4.5 casos por persona por año, siendo los astrocitomas pilocíticos y los meduloblastomas los subtipos histológicos más comunes.
Los tumores primarios del SNC son más comunes en la primera década de la vida, con una incidencia más alta en niños de 0 a 4 años de 5.2 por 100,000 personas por año más baja entre los 10 a 14 años (4.1 por 100,000 por persona
Los gliomas son tumores del SNC que vienen de precursores gliales y más comúnmente son diferenciados en el linaje de astrocitico u oligodendroglial. Pueden ocurrir en todas las edades y ubicados en cualquier parte del neuroeje. Según las características histológicas, los gliomas se agrupan en dos categorías: gliomas de bajo grado (GBG) y gliomas de alto grado (GAG). Esto también refleja la actual clasificación
de Organización Mundial de la Salud (OMS) que distingue los gliomas de bajo grado (OMS grado I/II) y alto grado (OMS grado III/IV).
Los GBG representan los tumores cerebrales más comunes en la edad pediátrica y constituye más del 20% de los tumores primarios cerebrales. La mayoría ocurren en el cerebelo, vías visuales y el diencéfalo. La incidencia de GBG en Estados Unidos se aproxima a 2 por 100,000 personas de 0 a 19 años de edad. Pueden estar asociados con síndrome de predisposición familiar de cáncer subyacente o síndromes neurocutáneos. Por ejemplo, niños con neurofibromatosis tipo 1 (NF1) tiene mayor riesgo de desarrollar GBG que involucren las vías visuales, encontrados en el 15 a 20 % de niños con NF1 y en niños con el complejo de esclerosis tuberosa (CET) tienen una mayor incidencia de astrocitoma de células gigantes subependimarias (SEGA por sus siglas en ingles), un subtipo de GBG.
Los GAG son relativamente raros en niños y comprenden aproximadamente el 4% de todos los tumores cerebrales diagnosticados en niños de 0 a 14 años y hasta 14% en edades de 10 a 19 años. Histológicamente, la mayoría de GAG son astrocitomas anaplásicos (OMS III) o glioblastomas (OMS grado IV).
Los GBG típicamente son tumores de crecimiento lento y la presentación clínica depende de la localización del tumor y la edad del paciente. Los síntomas resultan por la invasión al parénquima cerebral que lo rodea, compresión local del tejido cerebral o aumento de la presión intracraneal (PIC) generalizada. Los niños pueden presentar síntomas focales o difusos o una combinación de ambos. El aumento del a PIC puede producir dolores de cabeza, vómitos, irritabilidad y problemas de conducta. Los tumores en áreas elocuentes del cerebro pueden producir signos y síntomas focales que reflejan la función anatómica involucrada.
pediátricos tienden a ser isodenso o hipodenso en tomografía con variantes grados de cambios quísticos y realce con contraste. La porción solida del astrocitoma pilocítico realza con el contraste. Los tumores menos malignos tienden a tener una apariencia más focal con realce variable, con los de más bajo grado con muy poco realce. En contraste, con tumores de mayor grado, los GBG pediátricos no se acompañan típicamente de efecto de masa, edema o difusión restrictiva. Los quistes pueden ser levemente hiperintensos con respecto al LCR en secuencias T1 y FLAIR. Se realzan intensamente con el gadolinio. El 10% pueden presentar diseminación leptomeníngea.
Síntomas focales
• Convulsiones
• Ataxia
• Hemiparesia o debilidad
• Nistagmo
• Parálisis de nervios craneales
• Cambios sensoriales focales
• Disminución de la agudeza visual/ campos visuales
• Síndrome de Parinaud
• Diabetes insípida
• Retardo del crecimiento
• Afasia
Evaluación, diagnóstico y manejo
El diagnóstico de un GBG se realiza cuando los hallazgos característicos de neuroimagen se ven durante la evaluación de un trastorno neurológico como convulsiones o disfunción motora. Los GBG
Síntomas difusos
• Cefalea
• Rigidez de nuca
• Vómitos
• Letargia
• Deterioro cognitivo
• Cambio de conducta
• Convulsiones
• Irritabilidad
• Infantes:
aumento de la circunferencia craneal, separación de suturas. Abombamiento de fontanela, signo de sol poniente

La cirugía es el pilar del tratamiento para la mayoría de GBG pediátrico. La cirugía provee el tejido para la interpretación histopatológica y la caracterización molecular. Cuando es posible la resección completa puede ser curativa. En niños, cuando se realiza la resección quirúrgica de la lesión, la sobrevida de progresión libre a 5 años es cerca del 90% mientras que más de la mitad de los niños con resección subtotal tienen recurrencia de la enfermedad durante ese intervalo.
La mayoría de los GBG, especialmente los de vías ópticas, tallo cerebral y otras estructuras de la línea media, pueden no ser candidatos para cirugía o resección completa y la terapia adyuvante logra el control del tumor y prolonga la sobrevivencia. El uso de quimioterapia antes de la radioterapia, al inicio del diagnóstico y en la recurrencia ha demostrado la eficacia de la quimioterapia que puede retrasar o

evitar completamente la necesidad de irradiación craneal subsecuente.
La combinación de vincristina y carboplatino administradas semanalmente se ha usado desde finales de 1980, también la combinación de tioguanina, procarbazina, dibromodulcitol, lomustina y vincristina. El desarrollo de nuevas terapias incluye aquella dirigidas a inhibidores de BRAF, MEK, IDH. También se pueden aplicar terapias intratecales o intratumorales y se encuentra en desarrollo la inmunoterapia y vacunas tumorales.
Actualmente la irradiación está reservada por aquellos niños quienes no tienen opción quirúrgica o quimioterapéutica. Se evita en niños con riesgos a largo plazo de efectos cognitivos, vasculopatía y disfunción endócrina.


Bibliografía
1. https://www.cancer.gov/espanol/tipos/cerebro/paciente/gliomas-infantilesastrocitomas#_117
2. Stephen Ashwal, MD and Phillip L. Pearl, MD. Swaiman’s Pediatric Neurology, 6th Edition Principles and Practices, Elsevier 2025
3. de Blank P, Bandopadhayay P, Haas-Kogan D, Fouladi M, Fangusaro J. Management of pediatric low-grade glioma. Curr Opin Pediatr. 2019 Feb;31(1):21-27.
4. Figarella-Branger D, Appay R, Metais A, Tauziède-Espariat A, Colin C, Rousseau A, Varlet P. La classification de l’OMS 2021 des tumeurs du système nerveux central [The 2021 WHO classification of tumours of the central nervous system]. Ann Pathol. 2022 Oct;42(5):367-382.
5. https://www.pediatriaintegral.es/wp-content/uploads/2021/xxv07/04/n7-357-366_ AlvaroLasaletta.pdf
Las masas renales más frecuentes encontradas en la práctica clínica son los quistes simples, formaciones benignas que consisten en acúmulos de líquido rodeados por una membrana lisa. Se detectan con mucha frecuencia durante estudios de imágenes rutinario y, por lo general, no requieren tratamiento. En contraste, las lesiones sólidas y los denominados quistes complejos pueden albergar componentes histológicos malignos, lo que exige una evaluación más
A principios de los años 90, cuando iniciamos la consulta privada, los tumores renales eran poco frecuentes. Sin embargo, en las últimas dos décadas se ha observado un notable incremento en su detección. Este aumento puede atribuirse tanto a la mayor disponibilidad y resolución de los estudios de imágenes como a factores ambientales, como la contaminación del aire y los alimentos. Desde 1970, la incidencia del cáncer renal ha aumentado a un ritmo promedio del 3% anual.

El cáncer de riñón representa entre el 2 y el 3 % de todas las neoplasias presentan una alta mortalidad. Es más común en personas entre 60 y 70 años, con una relación hombre/mujer de 3:2. La mayoría de los casos son esporádicos; solo un 4 a 6 % se atribuye a causas hereditarias.
Los tumores renales suelen ser asintomáticos. Los síntomas clásicos —hematuria, dolor en flanco y masa palpable— son cada vez menos frecuentes. Actualmente, no existe un marcador aprobado para la detección temprana o
más común (70-85%), seguido por el carcinoma papilar (10-15%) y el carcinoma cromófobo (4-5%). Existen otras variantes menos frecuentes que escapan al alcance de este artículo.
Entre las causas más reconocidas del cáncer renal se destacan el tabaquismo, la obesidad y la hipertensión arterial. Otros factores incluyen la exposición a hidrocarburos aromáticos y, en particular, al tricloroetileno, relacionado con un riesgo de cáncer renal hasta seis veces mayor. Las causas genéticas suelen observarse en pacientes jóvenes y en los casos de tumores múltiples.
Las pruebas más eficaces para el diagnóstico de masas renales son la tomografía computarizada (TAC) y la resonancia magnética (RM) con contraste. Estas permiten evaluar no solo la presencia de la lesión, sino también su tamaño, localización, vascularización y posible invasión metastásica. Las lesiones menores de 4 cm tienen una probabilidad menor al 2 % de presentar metástasis.
En pacientes con función renal comprometida (filtrado glomerular < 30 ml/min), se recomienda evitar el uso de contrastes. Para quistes complejos (Bosniak III y IV), la captación del contraste, la presencia de calcificaciones y septos en su interior son signos claves para valorar su malignidad.
La ecografía renal sigue siendo útil, especialmente para distinguir entre lesiones sólidas y quísticas y para valorar la vascularidad del tumor. El PET/CT se utiliza en la evaluación
En cuanto al tipo histológico, el carcinoma de células claras es el

de metástasis, aunque aún no se dispone de un marcador específico de referencia, hay varios en estudios con buenas perspectivas.
Los estudios genéticos se indican en pacientes menores de 46 años, con tumores múltiples o antecedentes familiares.
El pronóstico del cáncer renal se establece en función del tamaño tumoral, necrosis tumoral, la presencia de metástasis (a distancia o linfovascular), el subtipo histológico, la invasión perirrenal y la presencia de síntomas.
La biopsia está indicada en los siguientes casos:
1. Dudas en el diagnóstico por imágenes (diferenciar entre lesiones hematológicas, metástasis o inflamatorias).
2. Tumores grandes o con metástasis, para establecer el tipo histológico y orientar el tratamiento.
3. Lesiones pequeñas a tratar con radiofrecuencia o termoablación.
4. No se recomienda realizar biopsia en pacientes con estado general
muy deteriorado que no recibirán tratamiento activo.
Cuando se realiza, se prefieren biopsias por cortes múltiples con agujas sobre aspiraciones con agujas finas.
Tratamiento
El enfoque terapéutico depende de varios factores: edad, estado general del paciente, tamaño y localización del tumor, y presencia de metástasis. Las opciones incluyen:
• Nefrectomía parcial o radical: indicadas en la mayoría de los casos.
• Terapias sistémicas (quimioterapia/ inmunoterapia): en casos avanzados o metastásicos.
• Enucleación tumoral: indicada en tumores múltiples, bilaterales o con componente familiar, buscando preservar la mayor cantidad posible de tejido renal funcional.
• Vigilancia activa: recomendada en pacientes de edad avanzada o con comorbilidades. También puede considerarse en tumores pequeños (< 3 cm), localizados y con crecimiento lento (< 5 mm por año), en pacientes que no desean cirugía.

Urológo Dr. Juan R. Caraballo Tavárez

El cáncer de laringe es sin lugar a dudas uno de los tumores más frecuentes en la cabeza y el cuello, posiblemente ocupando el primer lugar en nuestro país. Pero, ¿qué es la laringe? Bueno, la laringe es un órgano del cuerpo humano que se encuentra localizado en la parte anterior y central del cuello que podemos identificar fácilmente por lo que conocemos como la nuez Dentro de la laringe encontramos las cuerdas vocales las cuales son utilizadas para crear los sonidos que posteriormente
La laringe cumple tres funciones fundamentales; participa en la deglución de los alimentos y por lo tanto protege la vía aérea inferior del paso de restos de alimentos a los pulmones, participa en el proceso de la respiración y por último en la fonación o creación de la voz. El cáncer de laringe más frecuente es el carcinoma epidermoide y su aparición predomina de forma significativa en las cuerdas vocales, por lo que el primer síntoma o signo que despierta la sospecha es la ronquera o disfonía persistente. Otros síntomas podemos citar están la o dificultad respiratoria progresiva, trastorno
en la función deglutoria y el crecimiento de masas en el cuello.

Existen algunos factores que inciden de manera significativa en la aparición de este tipo de cáncer. El 95% de los tumores de laringe están asociados al consumo de cigarrillo. Otros factores que aumentan la probabilidad son el alcohol y el virus del papiloma humano VPH, este último con una participación cada vez más frecuente. El diagnóstico se realiza a través de la visualización directa de la laringe a través de un estudio en consultorio conocido
como videolaringoscopia. A través de este estudio observamos las cuerdas vocales, sus movimientos y las demás partes que conforman la laringe, por lo que se considera la herramienta más importante para establecer el diagnóstico. Otros elementos que ayudan a confirmar la enfermedad son los estudios de imágenes que finalmente concluye con la toma de biopsia de la lesión sospechosa.
El tratamiento depende fundamentalmente del estadio tumoral, que no es más que una clasificación del tumor basado en tres características fundamentales que son: el tamaño del tumor, la aparición o no de nódulos afectados en el cuello y por último si existe alguna evidencia de metástasis. Mientras más avanzado es el estadio tumoral menor será la supervivencia y por lo tanto un peor pronóstico. Se dice en estadios tempranos (I y II) los pacientes tienen más de un 90 % de posibilidad de curarse, mientras que en tumores avanzados (IV) esa posibilidad se reduce apenas a un 40% en el mejor de los casos.
El cáncer de laringe es un tumor que responde muy bien a las diferentes modalidades de tratamiento. En estadios tempranos se puede utilizar la radioterapia como único tratamiento con resultados excelentes. Otras opciones aplicables a esta clasificación están: la cirugía láser y la microcirugía. Todo dependerá de las condiciones clínicas, facilidades institucionales y preferencias del paciente que muchas veces dependen de su actividad laboral. Una persona que se dedica a trabajar a través del uso de su voz, como locutores, cantantes, profesores su prioridad principal siempre será la conservación de una buena calidad de la voz.

En los tumores más avanzados, (III y IV) las modalidades de tratamiento son más complejas y exigentes. En algunos casos se puede iniciar con quimioterapia más radioterapia pero en caso de que la laringe haya perdido sus funciones de forma irreversible, la laringectomía total sigue siendo el tratamiento de elección. Existen algunos procedimientos de resección parcial de la laringe con el objetivo de preservar el órgano pero cada caso debe ser individualizado y discutido con el paciente y sus familiares.
La prevención del cáncer de laringe se debe enfocar principalmente en la detección temprana del tumor en un paciente con síntomas o signos sospechosos y lo hacemos acudiendo a un especialista entrenado y capacitado para establecer el diagnóstico. De igual manera, el cese del consumo de cigarrillo y alcohol disminuye los riesgos de aparición del cáncer.

Dr. Darwin Romero
Otorrinolaringólogo, Cirujano Oncológico y Reconstructivo de Cabeza y Cuello
Torre Medicalnet B (809) 540-9775

Durante décadas, la oncología ha estado dominada por enfoques terapéuticos estandarizados. Protocolos sólidos, tratamientos generalizados y algoritmos clínicos permitieron grandes avances, pero también dejaron fuera un aspecto crucial del proceso: la individualidad del paciente. Hoy,en un mundo médico marcado por la innovación yla precisión,se hace cadavez más evidentequeelfuturodeltratamiento oncológico no está en la uniformidad, sino en la personalización.
Este artículo explora cómo la oncología contemporánea se
está transformando a través de herramientas biotecnológicas, análisis genéticos y un enfoque profundamente humano, para redefinir no solo el tratamiento del cáncer, sino la manera en que concebimos al paciente oncológico.
Más allá del tumor: el regreso a la persona
La medicina personalizada no es una idea nueva, pero hoy se ha convertido en una realidad palpable. Conocer la localización, el tipo y el estadio del tumor ya no es suficiente. La biología tumoral, el perfil molecular y los
factores genéticos individuales han pasado a ser piezas fundamentales en la toma de decisiones clínicas. El arte de la individualidad en oncología empieza por reconocer que dos pacientes con el mismo diagnóstico no son iguales. Uno puede responder favorablemente a una inmunoterapia, mientras otro requiere una terapia dirigida específica a una mutación presente en su ADN tumoral. Las diferencias no son errores de la ciencia, son señales de que estamos avanzando hacia una oncología más precisa, más eficiente y más humana.
Medicina de precisión: ciencia al servicio de lo único
Uno de los grandes avances ha sido la secuenciación genómica y su aplicación clínica. A través del análisis molecular del tumor, podemos identificar mutaciones específicas, alteraciones genéticas y biomarcadores que permiten seleccionar terapias dirigidas que aumentan la eficacia y reducen los efectos secundarios.
Por ejemplo, en cánceres como el de pulmón, mama o colon, la identificación de mutaciones como EGFR, HER2 o KRAS ha cambiado radicalmente la forma de tratar


estas patologías. Ya no se habla solo de cáncer de mama, sino de cáncer de mama HER2 positivo, lo cual tiene implicaciones terapéuticas completamente distintas. Además, herramientas como el perfil genómico completo (NGS, por sus siglas en inglés) están permitiendo detectar mutaciones con dianas terapéuticas incluso en tumores avanzados, llevando la medicina de precisión más allá de los protocolos y devolviendo la esperanza a pacientes que antes no tenían opciones.
Inteligencia artificial y datos: aliados de la personalización
La era digital también ha impactado la forma en que analizamos y tratamos el cáncer. La inteligencia artificial (IA) permite procesar grandes volúmenes de datos clínicos, genómicos, radiológicos y patológicos para generar patrones y predicciones de respuesta al tratamiento. Hoy, existen algoritmos capaces de sugerir opciones terapéuticas basadas en el perfil genético del paciente y la evidencia más reciente, lo que ayuda a los oncólogos a tomar decisiones más informadas y adaptadas a cada caso. Aunque la tecnología nunca reemplazará al juicio clínico, sí lo potencia.
La dimensión humana: más allá de la biología
Personalizar no es solo ajustar una quimioterapia a una mutación genética. También es reconocer la historia, los miedos, los valores y las prioridades del paciente. La oncología moderna debe ser tan precisa como compasiva. No basta con atacar las células malignas; debemos acompañar al paciente en cada etapa de su proceso, entender qué significa para él “vivir bien” y adaptar el

tratamiento a su proyecto de vida, no solo a su enfermedad. Aquí radica el verdadero arte: en escuchar, observar y acompañar. Cada decisión terapéutica debe ser compartida, conversada y adaptada, incluso si la ciencia permite otras opciones más agresivas. La individualidad también es emocional, espiritual y social.
y oportunidades
Adoptar una oncología personalizada plantea desafíos importantes:
• Accesibilidad a estudios moleculares de alto costo.
• Equidad en el acceso a terapias dirigidas e inmunoterapia.
• Formación continua del equipo médico para interpretar datos genómicos.
• Desarrollo de políticas de salud que promuevan este enfoque.
Pero también abre oportunidades únicas para revolucionar los resultados en cáncer, aumentar la sobrevida, mejorar la calidad de vida y restaurar la esperanza.
Estamos viviendo una revolución silenciosa, pero poderosa.
El paradigma del tratamiento oncológico está cambiando: ya no tratamos tumores, tratamos personas. Personas únicas, con historias, mutaciones y sueños diferentes.
El arte de la individualidad no es una moda,es un compromiso.Un compromiso con una medicina más justa, más precisaymás humana.
Una medicina que no solo cura, sino que respeta.Que no solo actúa,sino que acompaña.Y que no olvida que la ciencia más avanzada sigue teniendo su mayor sentido cuando está al servicio de cada ser humano.

Clínica

Torre Medicalnet B, Suite 704 809-373-1304

Alta eficacia incluso en adultos mayores y personas con inmunodepresión.
Reducción significativa del dolor neuropático postherpético.

Disponible en
Los tumores de párpado, ya sean benignos o malignos, son un motivo común de consulta en oftalmología. Los tumores benignos son mucho más frecuentes, y los más comunes incluyen quistes, nevus, queratosis seborreicas y verrugas. Los tumores malignos, como el carcinoma de células basales (CCB), el carcinoma de células escamosas y el carcinoma de glándulas sebáceas, suelen ser más comunes en personas de edad avanzada o con piel clara, y requieren un tratamiento más agresivo. deformidades, desviaciones del complejo areola-pezón y cicatrices evidentes, elevando la calidad de vida de las pacientes y su
Quistes: Pueden ser quistes de inclusión epidérmicos, quistes dermoides o quistes sebáceos.
Nevus: Son lesiones pigmentadas, como lunares o pecas.
Queratosis seborreicas: Son lesiones cutáneas benignas, ásperas y de color café.
Carcinoma de células basales (CCB): Es el tumor maligno más común del párpado.
Carcinoma de células escamosas: Es menos común que el CCB, pero puede aparecer en la piel del párpado.
satisfacción corporal y emocional. La cirugía conservadora ya no es sinónimo de secuelas visibles. Hoy, es posible ofrecer resultados funcionales y estéticos, incluso en contextos clínicos complejos.enfermedad que puede afectar a cualquier persona, pero la detección temprana y un estilo de vida saludable pueden marcar la diferencia en la lucha contra este padecimiento. información y la prevención son herramientas esenciales para reducir su impacto y mejorar la calidad de vida de quienes lo enfrentan.

Verrugas: Pueden ser verrugas virales o papilomas de células escamosas.
Chalazión: Inflamación de una glándula del párpado.
Tumores de células de Merkel: Son tumores neuroendocrinos raros, aunque pueden ocurrir en los párpados.
Carcinoma de glándulas sebáceas: Es más frecuente en Asia y puede ser difícil de distinguir del CCB.
Melanoma maligno: Es un tipo de cáncer de piel que puede desarrollarse en el párpado.




Tumores benignos: La extirpación quirúrgica es el tratamiento más común, aunque también se pueden utilizar otros métodos como el láser.
Tumores malignos: La extirpación quirúrgica, la radioterapia o la quimioterapia pueden ser necesarias.
Exposición al sol: La radiación ultravioleta puede aumentar el riesgo de cáncer de piel, incluido el cáncer de párpado.
Piel clara: Las personas con piel clara tienen mayor riesgo de desarrollar cáncer de párpado.
Edad: Los tumores malignos son más comunes en personas de edad avanzada.
Enfermedades sistémicas: Algunas enfermedades sistémicas pueden aumentar el riesgo de desarrollar cáncer de párpado.
Antecedentes familiares: Un historial familiar de cáncer de piel puede aumentar el riesgo.
Si notas un bulto o cambio en la piel de tu párpado, es importante consultar a un médico lo antes posible.
Protege tus párpados de la exposición al sol utilizando gafas de sol y protector solar.
Realiza exámenes de piel regulares para detectar cualquier cambio sospechoso

Dr. Faroche Melgen
Oftalmólogo especialista en párpados, vías lagrimares, órbita y bótox
809-541-6567
Introducción
Recibir un diagnóstico de cáncer nunca es una noticia fácil, ni para el paciente, ni sus familiares, ni para el equipo médico. Esta noticia suele venir acompañada de un sinnúmero de interrogantes, incertidumbre y preocupaciones. Si el tratamiento incluye una cirugía, es normal sentir cierta preocupación, no solo por la operación en sí, sino también por la anestesia. En este artículo intentaré explicar, de manera sencilla, qué es la anestesia, cómo se adapta a las personas con cáncer y qué hacer para llegar mejor preparado(a).
1. ¿Qué es la anestesia y por qué se usa en pacientes con cáncer?
La anestesia es un acto médico controlado que permite realizar procedimientos quirúrgicos sin dolor, por medio de medicamentos que pueden causar efectos desde la perdida de la consciencia —anestesia general, usualmente utilizada para cirugías grandes, por ejemplo de abdomen—, como el adormecimiento de una zona amplia —anestesia regional, utilizada frecuentemente para cirugía en las extremidades—,
como una zona pequeña— anestesia local, que se utiliza para procedimientos sencillos como en dermatología y algunas tomas de biopsia—.
Dependiendo del tipo de cirugía y de cada paciente, se puede utilizar cualquiera de estas o incluso combinarlas. En el caso del cáncer, frecuentemente se requiere cirugía para tratar la enfermedad o para aliviar síntomas, y allí la anestesia juega un papel clave en la seguridad y evolución del paciente.
2. ¿La anestesia es diferente para personas con cáncer?
Si, en cierto sentido. Las personas con cáncer pueden tener necesidades especiales y debe prestársele especial atención a ciertos aspectos. Por ejemplo, tratamientos como la quimioterapia o la radioterapia pueden afectar órganos importantes como el corazón, los pulmones o el hígado. También hay que evaluar el estado nutricional del paciente, si hubo ganancia o pérdida de peso, antecedentes de consumo de medicamentos o si existe dolor crónico.

Nunca deben olvidarse las enfermedades que estaban presentes antes del diagnóstico de cáncer, como son la hipertensión arterial, la diabetes o el asma y su nivel de control.
Todo esto se tiene en cuenta para que el anestesiólogo pueda elegir el tipo de anestesia más adecuado y seguro. Por todo esto, la consulta preanestésica es fundamental y debe hacerse con semanas de anticipación. Esto permite hacer ajustes en la medicación, solicitar otras valoraciones médicas si es necesario o realizar estudios adicionales, sin retrasar la cirugía.
3. ¿La anestesia puede afectar la evolución del cáncer?
Esta es una pregunta que ha despertado interés en los últimos años y aun no hay una respuesta definitiva. Lo que sí se sabe es que una anestesia bien planificada y personalizada no solo es segura, sino que conduce a mejores resultados y ayuda a una mejor y más rápida recuperación.
4. ¿Qué debes saber antes de una cirugía?
Es muy importante informar al equipo médico sobre el consumo de medicamentos y suplementos, incluso los naturales. También se debe mencionar antecedentes de alergias, problemas de sueño, ansiedad, dolor crónico, y no olvidar informar sobre el consumo de cigarrillos o alcohol, ya que esto puede influir en la recuperación.
Otro aspecto fundamental es recibir
información clara sobre lo que ocurrirá antes, durante y después de la cirugía. El cirujano debe explicar el tipo de procedimiento a realizar, por qué es necesario, cuánto tiempo puede durar y qué cuidados llevar a cabo posteriormente.
De igual forma, el anestesiólogo debe explicar qué tipo de anestesia se usará en cada caso, qué esperar y cuáles son las posibles molestias temporales o efectos secundarios. Esta información ayudará a comprender lo que va a ocurrir, disminuirá los miedos y permitirá al paciente participar activamente en su cuidado. Conocer estos detalles preparará mental y emocionalmente al paciente y familiares, lo cual les hará sentir acompañados, les permitirá tomar decisiones informadas y brindará mayor tranquilidad.
El día de la cirugía, seguir todas las indicaciones, entre las que podría mencionar: no comer ni beber antes del procedimiento (ayuno), ducha según la indicación, acudir con ropa cómoda y acompañado(a). Si existen dudas, comunícate con el equipo médico, estamos aquí para ayudarte, resolver inquietudes y hacer de esta experiencia lo más tranquila y segura posible.
5. ¿Qué pasa después de la cirugía?
Después de la cirugía, es normal sentir algo de malestar o dolor, pero este puede ser controlado con medicamentos. El equipo médico dará seguimiento cercano y constante a cada paciente durante la recuperación. En caso de sentir náuseas, mareos, dificultad para respirar o cualquier síntoma que cause preocupación, no dudar en
avisar. La comunicación es clave para una buena recuperación.
La anestesia es una parte fundamental del tratamiento quirúrgico en el cáncer. Con un equipo médico preparado y una buena comunicación, puedes sentirte seguro y acompañado. Como anestesiólogo mi deber es llevarte de la mano durante este proceso y ofrecerte siempre las opciones más beneficiosas para tu caso. Estar informado te ayuda a enfrentar el proceso con mayor tranquilidad y confianza.

Dr. Carlos Schrils Molina
Anestesiólogo


El melanoma es el tipo más agresivo de cáncer de piel que, aunque representa solo el 5% de los casos de cáncer de piel, es responsable de aproximadamente el 90% de las muertes relacionadas con este tipo de cáncer. Sin embargo, cuando se detecta en etapas tempranas, el melanoma tiene una tasa de curación cercana al 95% . De aquí, la importancia en la prevención.

El melanoma se origina en los melanocitos, células encargadas de producir melanina, el pigmento que da color a la piel. Aunque puede aparecer en cualquier parte del cuerpo, es más común en áreas expuestas al sol, como espalda, piernas, brazos y el rostro. También puede desarrollarse en zonas menos expuestas, como las palmas de las manos, las plantas de los pies o debajo de las uñas.
La exposición excesiva a la radiación ultravioleta (UV), ya sea del sol o de fuentes artificiales como las camas de bronceado, es el principal factor de riesgo para desarrollar melanoma. Otros factores incluyen antecedentes familiares, tener muchos lunares o lunares atípicos, piel clara, cabello rubio o pelirrojo, y ojos claros.
La detección temprana es clave para un pronóstico favorable. Una herramienta útil es la regla ABCDE:
de Asimetría: una mitad del lunar no coincide con la otra.
de Bordes: bordes irregulares, dentados o mal definidos.
de Color: variaciones de color dentro del mismo lunar.
de Diámetro: mayor a 6mm, aunque pueden ser más pequeños.
de Evolución: cambios en tamaño, forma, color o síntomas como picazón o sangrado .
Ante la sospecha de un lunar atípico, el dermatólogo realizará una evaluación clínica y puede utilizar herramientas como la dermatoscopia, que permite observar estructuras no visibles a simple vista. Si se considera necesario, se procederá a una biopsia para confirmar el diagnóstico. La profundidad del tumor, conocida como

“índice de Breslow”, es un factor determinante en el pronóstico y en la planificación del tratamiento .
El tratamiento del melanoma va a depender de la etapa en la que se diagnostique:
Etapas tempranas: la cirugía para extirpar el melanoma y un margen de piel sana circundante suele ser suficiente.
Etapas avanzadas: pueden requerir tratamientos adicionales como:
• Cirugía de Mohs: técnica quirúrgica que permite la extirpación precisa del tumor, preservando la mayor cantidad de tejido sano posible.
• Inmunoterapia: estimula el sistema inmunológico para atacar las células cancerosas.
• Terapias dirigidas: medicamentos que atacan mutaciones específicas en las células del melanoma, como las mutaciones BRAF.
• Radioterapia y quimioterapia: en casos donde otros tratamientos no son efectivos .
Recientemente, se ha aprobado una nueva terapia celular llamada lifileucel (Amtagvi) para pacientes con melanoma avanzado que no responde a otros tratamientos. Esta terapia utiliza células T del propio paciente para combatir el cáncer .
La mejor estrategia contra el melanoma siempre será la prevención:
• Evitar la exposición al sol durante las horas de mayor radiacion (10 a.m. a 4 p.m.).
• Usar protector solar de amplio

espectro con un SPF de al menos 30, reaplicándolo cada dos horas y después de nadar o sudar.
• Usar ropa protectora, sombreros de ala ancha y gafas de sol.
• Evitar las camas de bronceado.
• Realizar autoexploraciones mensuales de la piel y consultar al dermatólogo ante cualquier cambio sospechoso.
El melanoma es un cáncer de piel potencialmente mortal, pero altamente curable si se detecta a tiempo. La educación sobre los factores de riesgo, la autoexploración regular y las visitas periódicas al dermatólogo son fundamentales para una detección temprana y un tratamiento exitoso.

Dra. Claudia Hernández
Dermatóloga Clínica-Estetica, Tricóloga (809)-239-2233



Los testículos no descendidos – o criptorquidia – son un motivo frecuente de visita en la consulta de Cirugía Pediátrica y Urología Pediátrica. Sucede cuando uno o ambos testículos no se encuentran palpables en la bolsa escrotal. Esto puede notarse desde el nacimiento o más adelante en los primeros meses de vida, cuando los testículos que antes se veían en el saco escrotal ya no se ven o no permanecen allí la mayor parte del tiempo.
Esta entidad suele ser relativamente común, presentándose en el 2–4% de los niños, más comúnmente en prematuros (15–30%). Un 70% de los casos son unilaterales. En el 70–80% de los casos suele palparse el testículo al examen físico, mientras que un 6% suele encontrarse intraabdominal. Cuando el testículo no es palpable, hay un 15% de probabilidad de que esté ausente o se haya desaparecido.

Factores de riesgo
El peso al nacer es el principal factor de riesgo para la no bajada testicular, seguido de los antecedentes familiares. Además, otros posibles factores incluyen:
• Consumo de alcohol durante el embarazo (5 o más bebidas por semana, lo que puede aumentar el riesgo hasta 3 veces).
• Disruptores endocrinos químicos que interfieren con el equilibrio hormonal fetal normal.
• Fumar cigarrillos.
• Síndromes de malformaciones congénitas.
• Exposición al ftalato (di[2-etilhexilo] o DEHP)
• Uso de ibuprofeno.
• Fertilización in vitro.
• Diabetes materna.
• Obesidad materna.
• Exposición a pesticidas.
• Preeclampsia.
• Nacimiento prematuro antes del descenso testicular.
Diagnóstico y seguimiento
La orquidopexia (cirugía correctiva de la criptorquidia) debe considerarse si a los 6 meses de vida no se ha logrado un descenso espontáneo del testículo. Puede programarse entre los 6 meses y el primer año de vida, ya que hay evidencia histológica de anomalías testiculares antes de los 2 años.

Las indicaciones para la cirugía correctiva incluyen:
• Hernia: 60–90% de las criptorquidias se acompañan de una hernia.
• Injuria: Los testículos no localizados en la bolsa escrotal tienen mayor riesgo de lesión.
• Cosmético: Para normalizar la apariencia escrotal.
• Orquiepididimitis: Un testículo fijo en la bolsa tiene menor riesgo de inflamación que uno en el canal inguinal, donde está más expuesto a trauma.
• Infertilidad: El riesgo es mayor mientras más tiempo dure el testículo fuera del escroto. La infertilidad ocurre en un 10% de los casos unilaterales y en un 38% de los bilaterales.
• Torsión testicular: Fijar el testículo disminuye el riesgo de torsión.
• Razones psicológicas: Apariencia física normal del escroto.
Relación entre criptorquidia y tumor testicular
• Tumores: Existe un riesgo aumentado de malignidad en testículos no descendidos, con una incidencia de 0.05–1%. El riesgo aumenta según la ubicación: es mayor si el testículo está en posición abdominal que si es palpable. Un 74% de estos tumores corresponden a seminomas.
Seminoma: características y tratamiento
El seminoma es un tumor maligno de células germinales que afecta con mayor frecuencia al testículo, aunque también puede presentarse en el mediastino, retroperitoneo u otras localizaciones extragonadales. Es común en hombres de 15 a 34 años.

“
Es uno de los cánceres más tratables y curables, con una tasa de supervivencia superior al 95% si se detecta en etapas tempranas.

Los factores asociados a mayor riesgo incluyen:
• Antecedentes de (riesgo de 10 a 40 veces mayor; el 10% de los pacientes con criptorquidia desarrolla un tumor germinal).
• Exposición a compuestos químicos como organoclorados, bifenilos policlorados, PVC, ftalatos.
• Consumo de marihuana y tabaco.
• Antecedentes de parotiditis.
• Traumatismos testiculares.
• Antecedentes familiares de tumores testiculares.
• Malformaciones genéticas.
La orquiectomía radical está indicada en todos los estadios. La quimioterapia o radioterapia adyuvante dependerá de la estadificación clínica tras la orquiectomía inguinal.
Pronóstico y supervivencia
Según datos de SEER (Sociedad Americana del Cáncer):
• Estadio I (localizado): 99%
• Estadio II (regional): 96%
• Estadio III (a distancia): 73%
Los pacientes con cáncer testicular presentan mayor riesgo de cánceres secundarios debido a su corta edad al diagnóstico y a la exposición a tratamientos como radioterapia o quimioterapia. Estos pueden incluir mesotelioma, y tumores de pulmón, colon, vejiga, páncreas y estómago.
Conclusión
Los testículos no descendidos suelen ser detectados a tiempo si el bebé asiste regularmente a sus controles pediátricos, donde se le realiza un examen físico que incluye verificar la presencia testicular en el escroto. Si se detecta que los testículos no están fijados en su lugar, lo ideal es el seguimiento hasta los 6 meses de vida y, posteriormente, el referimiento a Cirugía Pediátrica o Urología Pediátrica para evaluar la necesidad de corrección quirúrgica.
La edad oportuna para corregir quirúrgicamente esta condición es entre los 6 meses y el año de vida, para disminuir el riesgo de daño testicular y complicaciones futuras, como la infertilidad y el cáncer testicular, especialmente el seminoma.

Dr. Pedro Sureda Cirujano Pediatra

Coautora:
Dra. Eliana Toral Cirujana Pediatra
MedicalNet Torre B, Suite 903 (809)-688-7006

El cáncer de endometrio es a sexta causa de cáncer en la mujer en el mundo. Es la neoplasia más común de origen ginecológico en países desarrollados con una incidencia ajustada por edad de 15,8 por 100.000 mujeres, y una mortalidad ajustada por edad de 2,5 por 100.000 mujeres, diagnosticándose anualmente más de 400.000 nuevos casos.

La incidencia viene aumentando entre el 0,5 y el 1% mundialmente en los últimos 20 años. La incidencia es menor en los países en vía de desarrollo como el nuestro.

El cáncer de endometrio afecta especialmente a mujeres que están en la postmenopausia en un 80 % de los casos, aunque en un 20 % se presenta en la edad fértil, y en un 5% antes de los 40 años. Su manifestación inicial es sangrado uterino anormal,lo que permite su diagnóstico temprano mediante el estudio histológico de una muestra del endometrio y se asocia a un buen pronóstico en un 70-80 % de los casos.
Los dos principales subtipos histológicos de cáncer de endometrio que se han utilizado tradicionalmente para la clasificación son el cáncer de tipo 1, que suele estar causado por factores que aumentan la exposición a estrógenos sin oposición, y el cáncer de endometrio de tipo 2, que no se asocia con estrógenos sin oposición.

del índice de masa corporal (IMC), la terapia de reemplazo estrogénico, los tumores secretores de estrógenos, la anovulación crónica, el tratamiento con tamoxifeno, la menarquia precoz y la menopausia tardía, que aumentan la exposición a estrógenos endógenos o exógenos a lo largo de la vida, así como la diabetes tipo II y la resistencia a la insulina. Por el contrario, para los cánceres no endometrioides de tipo 2, los factores de riesgo incluyen un IMC bajo, la paridad, la raza negra, los antecedentes de cáncer de mama y ser mayor de 55 años al momento del diagnóstico.
Varios factores epidemiológicos se asocian con la disminución del riesgo de cáncer de endometrio. Los anticonceptivos orales combinados de estrógeno y progestina o los dispositivos intrauterinos de levonorgestrel reducen el riesgo de cáncer de endometrio cada 5 años de uso hasta en un 33 %, en comparación



del riesgo en fumadoras frecuentes a medida que aumentan los años de consumo. Sin embargo, no se recomienda el consumo de tabaco por este efecto protector.
Los cánceres de endometrio confinados al útero pueden presentarse con síntomas mínimos de sangrado uterino anormal (SUA) o enfermedad avanzada con molestias y dolor pélvico-abdominal, diseminación linfática y peritoneal
generalizada, ascitis y, en raras ocasiones, incluso metástasis extraabdominales. El SUA es el síntoma más frecuente del
El Colegio Americano de Obstetras y Ginecólogos recomienda que ante un sangrado uterino anormal en una paciente premenopausica y posmenopausica se debe realizar un ultrasonido transvaginal, y si se opta por un procedimiento de dilatación y legrado, también se realice una histeroscopia debido a la mayor precisión que proporciona la visualización.
Se recomienda realizar la clasificación molecular en todos los carcinomas endometriales utilizando los marcadores de inmunohistoquímica como resultados subrogados del perfil molecular. El uso de los marcadores de inmunohistoquímica es considerada como la aproximación adecuada teniendo en cuenta la alta concordancia entre pruebas, permitiendo clasificar pacientes con cáncer de endometrio en los cuatro subtipos moleculares clínicamente relevantes.
El tratamiento inicial es quirúrgico, se remueve el útero, los anexos y la
evaluación ganglionar para no solo hacer la resección del tumor, sino también para definir el pronóstico y establecer el manejo complementario óptimo para cada caso, ya sea observación, hormonoterapia, quimioterapia, radioterapia, inmunoterapia, terapias target o combinación de estos.


Dr. Miguel Angel Urbáez
Ginecólogo Oncólogo

Torre Medical Net, Suite 404
809-368-0220 809-383-7586


Los cánceres de cabeza y cuello (HNC) son el quinto cáncer más común en todo el mundo, con más de 600,000 casos diagnosticados cada año [1]. El cáncer de amígdalas se ubica dentro de la categoría más amplia de cánceres de cabeza y cuello, específicamente como un tipo de cáncer orofaríngeo.
Las neoplasias de las amígdalas palatinas, las amígdalas linguales (base de la lengua), el paladar blando y la pared orofaríngea, colectivamente cánceres orofaríngeos, se encuentran entre los pocos cánceres con un rápido aumento de la incidencia en los últimos 30 a 40 años en varios países
desarrollados. En particular, estos aumentos se han producido a pesar de la disminución de la prevalencia del tabaquismo, un factor de riesgo importante para el cáncer de orofaringe. Se cree que los cambios en los comportamientos sexuales a través de la revolución sexual y el aumento de la exposición oral/ orofaríngea al Virus del Papiloma Humano (VPH) han contribuido al aumento de la incidencia de cáncer de orofaringe entre las cohortes nacidas durante y después de la década de 1940 [3].
de riesgo para el desarrollo de cáncer de amígdalas:
• Infección por el Virus del Papiloma Humano, en especial los serotipos 16 y 18. La gran mayoría (>70 %) de los cánceres de orofaringe en la actualidad son causados por la infección por VPH [3][5].
• Uso de tabaco.
• Consumo de alcohol.
• Otros:
• Estatus socioeconómico bajo.
• Pobre higiene dental.
• Condiciones de inmunidad disminuida.
en personas jóvenes. Poco más del 20 % (1 en 5) de los casos ocurren en personas menores de 55 años. A los hombres se les diagnostica cáncer de amígdalas de tres a cuatro veces más a menudo que a las mujeres [4].
Síntomas más comunes:

• Dolor de garganta (generalmente unilateral) que no mejora con el tratamiento convencional.
• Presencia de masa en el cuello.
• Dolor o dificultad para tragar, a menudo acompañada de pérdida de peso.
• Dolor de oído unilateral sin causa aparente en el oído afectado.
• Cambios en la calidad de la voz.
• Úlcera o masa visible en la amígdala.


Examen físico de la boca. Nasofaringoscopia.
Estudios de imagen: tomografía, resonancia magnética, PET scan,
Ultrasonido cervical con biopsia por aspiración con aguja fina.
Pruebas para el Virus del Papiloma Humano.
El tratamiento del carcinoma de gdalas incluye:
Carcinoma escamoso no queratinizante (asociado a VPH): 60–70 %.
• Carcinoma escamoso queratinizante: 20–30 %.
• Carcinoma indiferenciado: 5 %.
• Linfoma no Hodgkin: 1–3 %.
• Melanoma primario de amígdala (muy raro).
El método a utilizar dependerá del momento del diagnóstico (temprano o tardío), del tipo histológico y del tamaño del tumor, entre otros factores.
• El pronóstico de los pacientes con cáncer de amígdalas es bueno en la actualidad, con una sobrevida a 5 años superior al 85 % en los casos positivos para VPH.
• Esta baja a un 40–60 % en los pacientes fumadores y/o bebedores.
• Los pacientes diagnosticados en etapas tempranas tienen mejor pronóstico que los casos vistos tardíamente.
• El pronóstico suele ser muy bueno en los casos de linfoma de amígdalas.
• Los casos de carcinoma indiferenciado son los de peor pronóstico.

Otorrinolaringólogo
Neufcoeur PE, Arafa M, Delvenne P, Saussez S: Involvement of human papillomavirus in upper aero-digestive tracts cancers. Bull Cancer 2009, 96(10):941-50.
Gillison, M.L. et al. (2000). Squamous cell carcinoma of the tonsils: A molecular disease. Clinical Cancer Research, 6(4), 1093–1100.

Vacunación contra el VPH. Evitar tabaco y alcohol. Promoción de la sexualidad
Acudir al otorrinolaringólogo en caso de dolor de garganta persistente o que no mejore con los tratamientos usuales.

Kallunki, T. et al. (2015). Tonsillectomy and incidence of oropharyngeal cancers in Sweden. Cancer Epidemiology, Biomarkers & Prevention, 24(11), 1809–1813.
American Cancer Society. Facts & Figures 2024. Atlanta: American Cancer Society; 2024.
Devasena Anantharaman, Tarik Gheit, Tim Waterboer, Behnoush AbediArdekani. Infecciones por virus del papiloma humano y cánceres del tracto aerodigestivo superior: el estudio ARCAGE. JNCI: Revista del Instituto Nacional del Cáncer, Vol. 105, Nº 8, 17 de abril de 2013, pp. 536–545.
Lydiatt, W.M. et al. (2017). AJCC 8th Edition Cancer Staging Manual: Head and Neck Cancer. CA Cancer J Clin, 67(2), 122–137.
Gillison, M.L. et al. (2000). Squamous cell carcinoma of the tonsils: A molecular disease. Clinical Cancer Research, 6(4), 1093–1100.

Caso clínico
Juan Pancracio, un paciente de 71 años, llega a la consulta del urólogo con una lesión ulcerativa poco profunda de 1 cm en el surco balanoprepucial, no dolorosa ni supurativa, que ha aparecido hace un mes. El médico le prescribe antibióticos y cremas cicatrizantes, y le indica que vuelva en dos semanas para el seguimiento.
Don Juan se pierde y vuelve cinco meses después, esta vez acompañado por su esposa, doña Rosa, quien lo ha obligado a acudir a la consulta. Refiere que no ha mejorado. Al examinar a Juan, el urólogo observa que la lesión ahora mide 5 cm, tiene un aspecto mamelonado, necrótico y abigarrado, deforma el pene y sangra espontáneamente al roce. Despide un olor muy desagradable. Además, se palpan ganglios aumentados de tamaño en ambas ingles, muy duros y fijos al tacto.
Este es, lamentablemente, el panorama típico del cáncer de pene, la patología oncológica de mayor y más directo impacto en la virilidad, y posiblemente la neoplasia más agresiva de la Urología. El irremisible curso de esta enfermedad se vislumbra como dramático y acelerado, y predice un pronóstico sombrío.
A pesar de ubicarse en las penumbras de la Urología debido a su baja frecuencia y escasa salida oncológica, el cáncer de pene merece hoy día una atención renovada. Esta neoplasia no solo deteriora la salud física y empobrece la esperanza de vida, sino que también genera un profundo impacto psicológico y emocional en los enfermos y sus familiares. Es esencial que tanto los médicos como los pacientes comprendan la gravedad de la enfermedad, los desafíos en su manejo y la necesidad urgente de apartar los estigmas que la rodean. Aprendamos en estas líneas sobre su epidemiología, factores de riesgo, estrategias diagnósticas, tipos de tratamiento y, lo más importante, desterremos con conocimiento el prejuicio deshonroso que rodea este diagnóstico.
Epidemiología y problemática social
El cáncer de pene representa el 0.6 % de las neoplasias malignas del hombre. Aunque puede parecer infrecuente, las estadísticas recientes alertan sobre incrementos llamativos en su diagnóstico en países en desarrollo, donde el acceso a la atención médica es limitado. En países sudamericanos, como Brasil y Argentina, y en algunos países africanos, como Uganda, su incidencia es alta, representando el 2.2 % de los cánceres masculinos. En República Dominicana, se estima que el 1 % de las neoplasias del hombre son cánceres de pene.
Desafortunadamente, la percepción social negativa que rodea esta neoplasia —a menudo vinculada a la promiscuidad sexual y a la mala higiene— desanima a los hombres a solicitar atención temprana. En el 40 % de los casos, el hombre tarda más de un año en acudir a consulta. Este estigma debe ser desafiado, entendiendo que el cáncer es una enfermedad médica, no un juicio moral. La sensibilización social y la educación comunitaria son armas cruciales para fomentar la detección y el tratamiento precoz de esta patología. Con un diagnóstico temprano, el 80 % de los casos puede curarse.
El cáncer de pene se presenta como una lesión nodular, ulcerativa o fungoide, localizada en el glande, el surco balanoprepucial o el prepucio. Puede estar oculta por la fimosis. No suele doler, pero puede sangrar o supurar. Los tipos histológicos más frecuentes son el epidermoide y el basaloide, que representan el 70 % de los diagnósticos. Lamentablemente, son dos de los más agresivos.
El diagnóstico temprano es fundamental y marca el pronóstico. Una adecuada historia clínica y un minucioso examen físico son imprescindibles. La biopsia es el método diagnóstico gold standard. Toda lesión en el pene con mínima sospecha de cáncer debe ser biopsiada de entrada, sin opción a contemporizar. La estadificación por imágenes se realiza con tomografía de cuerpo completo y resonancia magnética de pelvis y muslos.
Tratamiento
El manejo depende del estadio en que se detecte:
• Estadios localizados: pueden
Los principales factores de riesgo son:
• Infección por genotipos de alto riesgo del virus del papiloma humano: presente en al menos el 65 % de los casos de cáncer de pene, aumentando el riesgo 5.9 veces.
• Fimosis y mala higiene: predisponen a inflamación crónica del glande y prepucio, aumentando el riesgo 3 veces.
• Balanitis a repetición: aumenta el riesgo 9.4 veces.
• Tabaco: aumenta el riesgo 4 veces.
abordarse con cirugías conservadoras como fulguración láser, glandectomía, exéresis local ampliada y cirugía de Mohs. Esta última consiste en una resección por etapas hasta lograr un margen sano mínimo (3 mm), lo que garantiza la máxima conservación de la apariencia y función del órgano.
• Estadios localmente avanzados: o cuando no es posible la resección con bordes quirúrgicos adecuados, se realiza penectomía parcial o total, más reconstrucción urinaria. Es el escenario más mutilante, pues la conmoción psicológica de la falectomía resulta dramática para el paciente.
Además, se asocia un riesgo de micrometástasis inguinales de más del 25 %, por lo que a la cirugía se suma la exéresis de ganglios inguinales y pélvicos. La linfadenectomía conlleva una probabilidad del 50 % de complicaciones postoperatorias, incluso en centros urooncológicos con vasta experiencia.
• Estadios metastásicos: se manejan con quimioterapia. Sin embargo, el pronóstico es nefasto, con apenas 37 % de sobrevida a 5 años. Actualmente se ensayan fármacos inmunoterapéuticos con resultados preliminares esperanzadores.




Los estadios avanzados deterioran rápidamente al paciente. Las adenopatías tumorales pueden ulcerar la piel, infectarse y supurar, y los tratamientos resultan inefectivos para mejorar las condiciones generales del paciente. La medicina paliativa, la atención psicológica, el control del dolor y, más importante aún, el apoyo familiar, son los pilares del manejo en estas etapas. La claudicación familiar es frecuente y comprensible, por lo que la infraestructura hospitalaria debe estar disponible para el albergue del enfermo terminal.


El enfoque multidisciplinario — que incluye urólogos, oncólogos, psicólogos y equipos de cuidados paliativos— es fundamental para mejorar la calidad de vida del paciente.
Impacto psicológico y calidad de vida
El diagnóstico de cáncer de pene no solo plantea desafíos en la salud física, sino también en la mental. Los pacientes a menudo enfrentan sentimientos de ansiedad, depresión y cambios en la identidad sexual. Es importante implementar programas de apoyo psicológico desde el inicio del tratamiento. La sensibilización y la educación del paciente sobre su condición forman parte integral del manejo.

El cáncer de pene continúa siendo el desafío por excelencia de la urooncología contemporánea. Es una enfermedad que invita a la urgencia y a la acción. Sus implicaciones obligan a la comunidad médica a desafiar el oprobio que la rodea y a comprometerse con la educación del paciente, el diagnóstico temprano y el manejo multidisciplinario. Estos enfoques son esenciales para mejorar los resultados y la calidad de vida de los afectados.
Hacemos un llamado a la acción: unámonos para iluminar este tema, armémonos de conocimiento y empoderemos a nuestros pacientes para que busquen atención oportuna, acertada y temprana.

Dr. Juan Félix González
Endourología y Cirugía Urooncológica
Servicio Integral de Urología, Andrología y Reproducción (SIUAR) – Medicalnet B





La glándula tiroides es un órgano importante del sistema endocrino, tiene forma de mariposa, y está localizada en la región anterior del cuello. Su función es producir hormonas que se vierten al torrente sanguíneo para ser dirigidas a todo el organismo.
Las hormonas tiroideas tienen una función en la utilización de energía por nuestro organismo, regulación del metabolismo, mantener la temperatura corporal, actúan en la función del cerebro, músculos, corazón, para que dichos órganos funcionen adecuadamente. Como otro órgano de nuestra economía, la glándula tiroides puede verse afectada por múltiples enfermedades siendo el objeto de este artículo ofrecer información sobre el cáncer de tiroides.
En las últimas décadas ha aumentado significativamente el diagnóstico de cáncer de tiroides, especialmente el tipo papilar, debido al amplio uso de imágenes como la sonografía. Es importante racionalizar el diagnóstico y tratamiento, ya que su comportamiento varía desde tumores de progresión lenta hasta altamente agresivos.
La aplicación de sistemas de evaluación de riesgos de imágenes en la sonografía y citología, y la incorporación de estudios moleculares, permite estratificar los casos para seleccionar la terapia adecuada. Es mandatorio no confundir el sobrediagnóstico, que puede tener consecuencias negativas, con el diagnóstico temprano, que es crucial en tumores agresivos.
Para evitar tratamientos innecesarios que impactan al paciente y al sistema de salud, las guías actuales de la ATA (American Thyroid Association) recomiendan no realizar punción con aguja fina (PAAF) en nódulos menores de 1 cm sin características sospechosas.
El cáncer de tiroides representa el 3% de los diagnósticos oncológicos globales y predomina en las mujeres (75%) de 30 a 50 años. La incidencia de cáncer de tiroides ha aumentado en 3% anual en Estados Unidos y hasta 10 veces en Asia debido a diagnósticos sonográficos en estadíos tempranos en nódulos pequeños, factores genéticos y ambientales.
Los tipos de cáncer de tiroides se dividen en:
Carcinomas diferenciados de tiroides, que incluye: los carcinoma papilares, carcinomas foliculares y sus variantes; que representan el mayor porcentaje de los mismos y, a su vez, los de mejor pronóstico y supervivencia. Suelen ser no agresivos.
El carcinoma papilar de tiroides representa entre el 80-85% de todos los cáncer de tiroides, con supervivencia a 10 años superiores al 90%. Puede ocurrir a cualquier edad, es de crecimiento lento y suele extenderse a ganglios loco regionales en el cuello. A pesar de ello, tiene un excelente pronóstico.
El carcinoma folicular representa alrededor del 5% a 15% de todos los cáncer de tiroides y puede asociarse a metástasis a distancia como pulmón y hueso debido a que se expande a través del torrente circulatorio.
Existen otros tipos de cáncer de tiroides tales como el medular que representa alrededor del 2% de todos los carcinomas tiroideos. Hay una asociación familiar en un 25% siendo un 75% de ellos esporádico, es decir, sin relación a la herencia.
El carcinoma anaplásico de tiroides constituye la variante más agresiva de cáncer de tiroides pero es muy rara y su frecuencia se sitúa en menos de un 2% con supervivencia promedio
inferior a 6 meses.
El linfoma tiroideo es otra variante, muy rara, de malignidad.
Nos centraremos en los carcinomas diferenciados de tiroides debido a su frecuencia y diagnóstico cada vez más común.
¿Qué factores se invocan en el riesgo de desarrollar cáncer de tiroides?
1. Historia de exposición a radiaciones durante la infancia
2. Antecedentes familiares de cáncer de tiroides
3. Uso de radioterapia para el tratamiento de otros tipos de cáncer como linfoma de Hodkings, cáncer de mama.
4. Exposición a radioactividad como el accidente de Chernobyl y Fukushima.
5. Se invocan factores medioambientales, los llamados perturbadores o disrruptores endocrinianos.
6. Exposición a radiaciones ionizantes.
¿Qué síntomas pueden presentarse en el cáncer de tiroides?
La mayoría de las veces el cáncer de tiroides se presenta como un nódulo en la glándula descubierto de forma incidental y que no produce síntomas. Su descubrimiento por lo usual está asociado a la realización de sonografías de tiroides como parte de chequeos rutinarios lo cual ha incidido en un incremento de su diagnóstico a nivel mundial. El examen físico del cuello por su médico, los estudios de imágenes tales como tomografías y doppler carotídeos pueden conllevar al

hallazgo de nódulos tiroideos de forma incidental.
Los síntomas asociados a cáncer cuando están presentes, consisten en un abultamiento en el cuello que el paciente nota por sí mismo, o es descubierto por su médico al realizarle un exámen físico. Solo 30% de los pacientes presentan nódulos palpables. En ocasiones, por la dimensión del nódulo se produce molestias al tragar, presencia de ronquera o disfonía debido a la invasión por el cáncer del nervio laríngeo recurrente, dificultad para respirar y tos.

Es mandatorio realizar un exámen físico exhaustivo del cuello. Se requerirá un sonografía de tiroides y región cervical y acorde con los resultados, existen parámetros para sospecha de nódulos cancerígenos los cuales incluyen:
a) Nódulos con contornos irregulares
b) Más altos que anchos
c) Presencia de microcalcificaciones o punteados ecogénicos internos
d) Marcadamente hipoecogénicos en la sonografía
e) Sólidos
f) Extensión extratiroidea
g) Presencia de ganglios locoregionales sospechosos en la sonografía.
Estas características sonografícas fueron establecidas en las guías de 2016 (Task Force American Thyroid Association).
La sonografía de tiroides es el exámen de elección para la evaluación inicial de los nódulos tiroideos. El protocolo manda a realizar punción por aspiración por aguja fina a aquellos nódulos con alta sospecha sonográfica de malignidad. La citología por PAAF tiene una eficacia diagnóstica de 95% para establecer riesgo de malignidad utilizándo el sistema de Bethesda para su clasificación de riesgo. El diagnóstico certero se establecerá tras la remoción del nódulo quirúrgicamente y su análisis histopatológico.
En la actualidad existen plataformas comerciales basadas en análisis múltiples de identificación de anomalías genéticas mediante secuenciación (ThyroseqV3, Afirma GSC, ThyrGeNext, etc.).
Estos estudios constituyen una herramienta valiosa en las citologías indeterminadas. Sin embargo, su elevado costo y la no disponibilidad en nuestro país, limita su uso.
El tratamiento de elección para el cáncer de tiroides es su extirpación quirúrgica. La extensión de la cirugía será definida por el tamaño del tumor, la propagación del tumor fuera del tiroides, la presencia o no de ganglios metastásicos.
Los tipos de cirugía a realizar son: lobectomía, tiroidectomía total, hemitiroidectomía, disección ganglionar cervical y sus variantes. Es muy importante hacer la elección correcta del tipo de cirugía acorde con las características del carcinoma tiroideo y su riesgo de estratificación.
El cáncer de tiroides se cura en la mayoría de las ocasiones solo con cirugía, sin embargo existen condiciones en que el cáncer
tiene extensión fuera del tiroides, metástasis a ganglios, que cambian el riesgo de recurrencia y que condicionan la implementación de terapia ablativa con yodo radiactivo.
La terapia ablativa con yodo se utiliza debido a que las células tiroideas y los carcinomas diferenciados de tiroides absorben el yodo y este destruye cualquier remanente tiroideo después de la tiroidectomía. El yodo radioactivo no está exento de complicaciones. El análisis de

potenciales riesgos y beneficios de la dosis a administrar, debe ser discutido con su médico. La administración de yodo radioactivo está recomendada según el riesgo de estratificación del tumor. En los tumores de alto riesgo, el radioyodo ha demostrado eficacia al mejorar la tasa de recidiva y la mortalidad. En casos avanzados de la enfermedad se han incorporado tratamientos sistemáticos oncoespecíficos.
En conclusión, el abordaje del cáncer de tiroides es mulltidisciplinario. El cáncer de tiroides, especialmente en sus variantes diferenciadas tiene un pronóstico favorable. En la actualidad se implementa el abordaje individual de cada caso garantizándo de esta forma un tratamiento y seguimiento más eficiente.

Dra. Sylvia Batista
Cirujana General, laparoscopista, especialista en cirugía de tiroides y paratiroides.
El rol de la mujer en la sociedad ha evolucionado de forma notable en las últimas décadas. Hoy, la mujer ocupa espacios de liderazgo, decisión y protagonismo, también en lo relacionado con su salud. Este cambio social ha tenido un impacto directo en el enfoque médico, especialmente en áreas tan sensibles como el cáncer de mama, donde históricamente las pacientes sufrían no solo las consecuencias físicas de la enfermedad, sino también el peso emocional de cirug mutilantes.

En el pasado, cuando los diagnósticos se realizaban en etapas avanzadas, la cirugía era muchas veces la única opción terapéutica disponible. Como resultado, miles de mujeres perdían sus mamas sin posibilidad de reconstrucción inmediata ni atención a su bienestar emocional. Hoy, gracias al avance científico y a una sociedad más informada, nos enfrentamos a un nuevo paradigma: el de una cirugía mamaria personalizada, conservadora y estética, donde la oncología y la cirugía plástica se integran para ofrecer soluciones más humanas y efectivas.

La cirugía oncoplástica: un enfoque integral
La cirugía oncoplástica representa uno de los avances más significativos en el tratamiento del cáncer de mama. Esta técnica combina los principios de la cirugía oncológica con los de la cirugía plástica y reconstructiva, permitiendo extirpar el tumor de forma segura y, al mismo tiempo, preservar o restaurar la forma y simetría de la mama. Esta integración permite evitar
deformidades, desviaciones del complejo areola-pezón y cicatrices evidentes, elevando la calidad de vida de las pacientes y su satisfacción corporal y emocional. La cirugía conservadora ya no es sinónimo de secuelas visibles. Hoy, es posible ofrecer resultados funcionales y estéticos, incluso en contextos clínicos complejos.enfermedad que puede afectar a cualquier persona, pero la detección temprana y un estilo de vida saludable pueden marcar la diferencia en la lucha
contra este padecimiento. La información y la prevención son herramientas esenciales para reducir su impacto y mejorar la calidad de vida de quienes lo enfrentan.
Indicaciones amplias y técnicas versátiles
La cirugía oncoplástica no es exclusiva para ciertos tipos de pacientes: puede aplicarse en tumores grandes o pequeños, en mamas de diferentes tamaños y en diversas localizaciones anatómicas. Se emplean desde técnicas simples como el desplazamiento glandular, hasta procedimientos más complejos como la reconstrucción con colgajos locales o compensación geométrica.
Estas técnicas permiten realizar resecciones más amplias sin comprometer la estética, lo cual es especialmente valioso en pacientes que han recibido tratamiento neoadyuvante (como quimioterapia) o en tumores no palpables, donde se utilizan sistemas de marcaje previo para lograr una resección precisa con márgenes libres de enfermedad. Además, favorece la conservación mamaria en casos que tradicionalmente indicaban mastectomía, lo que reduce el impacto emocional del diagnóstico y mejora la adherencia a los tratamientos posteriores.
De hecho, el riesgo de recurrencia local se reduce hasta en un 25% en algunos casos, desafiando la idea aún presente en algunos pacientes de que “quitarlo todo” es sinónimo de mayor seguridad. Por otro lado, las técnicas oncoplásticas permiten preservar la imagen corporal y la autoestima de las pacientes. Muchas veces, el abordaje quirúrgico incluye la simetrización de la mama sana, buscando un resultado armonioso y favoreciendo la percepción positiva del cuerpo, que es clave durante el proceso de recuperación.
¿Cuál es nuestro objetivo? preservar la vida con dignidad
El propósito final de la cirugía oncoplástica no es solo curar, sino hacerlo con dignidad. La calidad de vida, el bienestar psicológico y la imagen corporal son ahora variables tan importantes como la supervivencia en el abordaje del cáncer de mama.
Como mastólogas y cirujanas oncoplásticas, nuestra responsabilidad es múltiple: asegurar márgenes libres de enfermedad, realizar procedimientos seguros, preservar la simetría mamaria y acompañar emocionalmente a cada paciente en su proceso de sanación. Hoy, gracias a la cirugía oncoplástica, el cáncer de mama se enfrenta con más ciencia, más opciones y, sobre todo, más humanidad.

Menos complicaciones, más bienestar
Resultados oncológicos y estéticos
Uno de los pilares de la cirugía oncoplástica es que los resultados oncológicos no se ven comprometidos. Diversos estudios han demostrado que, cuando se combina con radioterapia, esta cirugía ofrece índices de supervivencia iguales o superiores a la mastectomía, especialmente en estadios tempranos.
La evolución de las técnicas quirúrgicas también ha permitido minimizar las complicaciones relacionadas con la cirugía axilar. Gracias a la técnica del ganglio centinela, es posible evitar en muchos casos el vaciamiento axilar completo, lo cual reduce significativamente la morbilidad postoperatoria como el linfedema, el dolor crónico y la limitación funcional del brazo.
Asimismo, se procura realizar incisiones de baja visibilidad, siempre que sea clínicamente viable, garantizando un resultado estético más discreto y respetuoso con la anatomía de cada paciente.

Dra. Wilma A. Álvarez
Grullón
Cirujana Mastóloga y Oncoplástica
Dra. Anjelina Taveras
Ovalles
Cirujana Mastóloga y Oncoplástica

Torre Medicalnet B, Suite 704
809-373-1304
Integrando el cáncer y la cardiología en la era de la
por tratamientos antineoplásicos.

La enfermedad cardiovascular y el cáncer son las dos causas más importantes de mortalidad a nivel mundial y en algún momento ambas entidades van a coexistir, tanto por compartir mecanismos fisiopatológicos, como por las nuevas terapias para el manejo de las neoplasias y las estrategias de detección precoz que han logrado un gran impacto en la sobrevida de los pacientes, alcanzando la cura hasta en un 90 % de los casos o convirtiéndola en una patología crónica.
En el 10 % de los pacientes con cáncer se afectará el sistema cardiovascular, 30 % de los pacientes con enfermedad cardiovascular (ECV) desarrollaran cáncer, 30 % de los pacientes que reciben un tratamiento antineoplásico tendrán complicaciones cardiovasculares y el 20 % de los pacientes de más de 70 años con un diagnóstico reciente de cáncer, tendrá factores de riesgo o una enfermedad cardiovascular previamente establecida; por estas razones surge la cardio-oncología.
La cardio-oncología es un campo multidisciplinario que se enfoca en la prevención, diagnóstico y tratamiento de enfermedades cardiovasculares en pacientes con cáncer, especialmente la toxicidad cardiovascular inducida
Los pacientes con enfermedad más avanzada suelen ser sometidos a múltiples modalidades de tratamiento y con mayor agresividad, incluidas la radioterapia, quimioterapia citotóxica, anticuerpos e inhibidores de diana molecular, para interrumpir diferentes vías de señalización y puntos de control inmunológicos que se han visto implicados en el desarrollo de cardiotoxicidad.
Los mecanismos para el desarrollo de estas complicaciones son complejos y varían según el tipo de fármaco y modalidad del tratamiento, de manera general pueden tener mecanismos directos sobre el cardiomiocito o indirectos como interrupciones de vías de señalización o favorecer la síntesis de diferentes mediadores con un impacto no deseado en la función cardiovascular.
Las complicaciones cardiovasculares relacionadas a los diferentes
fármacos son: la disfunción del ventrículo izquierdo, insuficiencia cardíaca, hipertensión arterial, prolongación del intervalo QT, arritmias, infartos, tromboembolismo arterial o venoso, hipertensión pulmonar y enfermedad arterial periférica, todo esto se define como toxicidad cardiovascular.
La evaluación cardiovascular es personalizada y debe estar centrada en el riesgo del fármaco y hacia el paciente, va dirigida a 5 elementos claves: valoración del riesgo inicial, vigilancia durante el tratamiento, manejo de la toxicidad cardiovascular, valoración al final del tratamiento y seguimiento a largo plazo de los supervivientes.
Es preciso identificar, no solo los factores de riesgo que tiene el paciente, sino también los fármacos que utiliza y que podrían tener interacciones con el tratamiento antineoplásico e influir en el sistema cardiovascular.

De manera general, la evaluación inicial del paciente, debe incluir:
1. Interrogatorio y examen físico: identificación de factores de riesgo cardiovascular, ECV, tipo de cáncer y tratamientos previos.
2. Electrocardiograma de 12 derivaciones: para identificar las características basales y medir el intervalo QT.
3. Biomarcadores: la determinación de troponinas y péptidos natriuréticos se realizará al inicio y durante el tratamiento, ya que nos ayudan a identificar el desarrollo de toxicidad.
4.
Imágenes cardiovasculares: la idónea en el paciente oncohematológico sería la que nos aporte información exacta y reproducible, que sea fácilmente accesible, económicamente sostenible y cuyo análisis e interpretación sean sencillos, por lo que el ecocardiograma cumple estas características. Con el valoramos la fracción de eyección del ventrículo izquierdo en modalidad biplano y tridimensional, el strain global longitudinal, así como el ventrículo derecho.
5. Pruebas complementarias para identificar posibles factores de riesgo y/o ECV, tales como: perfil de lípidos, glucosa, HbA1C, y pruebas de función renal.
Tomando en cuenta que el cáncer aumenta el riesgo de enfermedad cardiovascular, se consideran pacientes con alto riesgo de desarrollar toxicidad:
- Edad menor a 10 años o mayor de 75 años
- Pacientes con Hipertensión Arterial o Diabetes Mellitus 2 o enfermedad renal crónica o alguna enfermedad cardiovascular previamente establecida.
- Pacientes con exposición actual o en el pasado al tabaco
- Fracción de Eyección del Ventrículo Izquierdo basal < 50 %
- Biomarcadores elevados antes de iniciar la terapia
- Radioterapia mediastínica previa - Pacientes que hayan recibido quimioterapia previa con antraciclinas o trastuzumab, solos o combinados.
Por lo antes señalado, todo paciente que tiene diagnóstico de cáncer, antes de iniciar el tratamiento, debe tener una evaluación cardiovascular completa y control estricto. Esta evaluación permite estratificar el riesgo y brinda herramientas al hemato-oncólogo para tomar la decisión terapéutica en función del mismo. Esta evaluación cardiovascular no se limita al inicio del tratamiento, sino que debe hacerse de manera periódica e incluso durante los años posteriores a la remisión en los sobrevivientes. Esto permite establecer estrategias para la detección y tratamiento precoz de la toxicidad cardiovascular.
El trabajo en conjunto del oncólogo y el cardiólogo es esencial para evitar las interrupciones del tratamiento y obtener mejores resultados durante y después del mismo.

Dra. Annie Gisselle Ramírez Peña
Cardióloga Intensivista 809-566-8000

Medicalnet B




El virus del papiloma humano (HPV, por sus siglas en inglés) es una de las infecciones de transmisión sexual más comunes en el mundo. Aunque durante años se ha enfocado su prevención en mujeres —principalmente por su relación con el cáncer de cuello uterino— hoy se reconoce la importancia de vacunar también a los hombres. Esta medida no solo protege la salud individual masculina, sino que también es clave para controlar la transmisión del virus a nivel poblacional.
¿Qué es el HPV y cómo afecta a los hombres?
El HPV es un grupo de más de 100 virus relacionados. Algunos tipos de HPV causan verrugas genitales, mientras que otros están asociados con diversos tipos de cáncer. En el caso de los hombres, el virus puede causar:
• Cáncer de pene
• Cáncer anal
• Cáncer oro-faríngeo (que afecta garganta, lengua y amígdalas)
• Verrugas genitales persistentes y de difícil tratamiento






está aprobada para utilizarse hasta los 45 años de edad.
La vacunación temprana, antes del inicio de la actividad sexual, garantiza una máxima eficacia. Aun así, los hombres que ya han iniciado su vida sexual pueden beneficiarse, ya que probablemente no han estado expuestos a todas las cepas del virus.


Conclusión
Vacunar a los hombres contra el HPV no es solo una opción inteligente: es una decisión responsable que puede salvar vidas. Protege al individuo, protege a su pareja, y ayuda a reducir la carga del cáncer relacionado con este virus. La inclusión del hombre en las estrategias de prevención del HPV es un paso necesario hacia una salud pública más equitativa, efectiva y sostenible.
Hablar de prevención es hablar de futuro. La vacuna del HPV o Papiloma humano virus en hombres es parte esencial de ese futuro.
Ante la duda visite su Urólogo.
¿Por qué es importante vacunar también a los hombres?
1. Protección directa: reduce el riesgo de cánceres relacionados con el HPV y de verrugas genitales.
2. Prevención de la transmisión: al reducir la cantidad de personas infectadas, se corta la cadena de contagio y se protege a las parejas sexuales.
3. Igualdad en salud: ofrecer la vacuna a ambos sexos combate el estigma y la falsa idea de que el HPV es un “problema de mujeres”.
4. Reducción de costos a largo plazo: prevenir enfermedades siempre es más económico que tratarlas, especialmente en el caso de cánceres avanzados.
La vacuna contra el HPV ha sido ampliamente estudiada y utilizada en todo el mundo durante más de una década. Es segura, bien tolerada y altamente efectiva. Sus efectos secundarios son leves, como dolor en el sitio de aplicación, fiebre leve o malestar general. Los beneficios superan con creces cualquier posible reacción adversa.
Uno de los mayores desafíos sigue siendo la falta de información. Muchos padres y hombres adultos aún no conocen los riesgos del HPV ni saben que la vacuna está disponible para ellos. En algunos países, la vacunación en varones ya forma parte del calendario oficial; en otros, aún es una recomendación pendiente de implementar masivamente.
Es importante que profesionales de la salud, educadores y familias trabajen juntos para crear conciencia sobre esta herramienta preventiva. La conversación sobre salud sexual debe incluir a todos, sin distinción de género.

Dr. Pablo Mateo
• Urólogo-Cirujano
• Trasplante Renal
• Cirugía Asistida por Robot Da Vinci
• Cirugía con Láser Thulio
• Uro-Oncología
• Rezūm para Próstata
• Implante de Pene
• Ondas de Choque (Renova) para Disfunción Eréctil
Para citas: (849)-456-3692

Los gliomas son un tipo de tumor cerebral que se origina en las células gliales, las cuales brindan soporte estructural y funcional a las neuronas. Representan aproximadamente el 30% de todos los tumores cerebrales y el 80% de los tumores malignos del sistema nervioso central. Su clasificación, diagnóstico y tratamiento han evolucionado significativamente en las últimas décadas, especialmente con el avance de las técnicas de neuroimagen y la biología molecular.
Clasificación y tipos
Los gliomas se clasifican principalmente según el tipo de célula glial que los origina y su grado de malignidad, de acuerdo con los criterios establecidos por la Organización Mundial de la Salud (OMS). Los tipos más comunes son:
1. Astrocitomas: Derivan de los astrocitos y pueden ser de bajo grado (grado I y II) o alto grado (grado III, llamado astrocitoma anaplásico, y grado IV, conocido como glioblastoma multiforme o GBM). El glioblastoma es el tipo más agresivo y común de glioma.

2. Oligodendrogliomas: Originados en los oligodendrocitos, suelen crecer más lentamente que los astrocitomas y tienden a responder mejor al tratamiento. Se clasifican como grado II o III.
3. Ependimomas: Provienen de las células ependimarias que recubren los ventrículos cerebrales y el canal central de la médula espinal. Pueden afectar tanto a niños como a adultos y varían en agresividad.
Existen también gliomas mixtos, que presentan características tanto de astrocitomas como de oligodendrogliomas, aunque esta categoría ha sido redefinida con el uso de marcadores moleculares.
Factores de riesgo y causas
La etiología de los gliomas aún no se comprende completamente. Sin embargo, se han identificado ciertos factores de riesgo, como la exposición a radiación ionizante, antecedentes familiares de tumores cerebrales y ciertas alteraciones genéticas. No hay evidencia sólida que relacione el uso de teléfonos móviles con un aumento del riesgo de gliomas.
Síntomas
Los síntomas de los gliomas dependen de su localización, tamaño y velocidad de crecimiento. Los más comunes incluyen:
• Dolores de cabeza persistentes
• Convulsiones
• Déficits neurológicos focales (como debilidad, dificultad para hablar o alteraciones visuales)
• Cambios en la personalidad o el estado mental
• Náuseas y vómitos debido a aumento de la presión intracraneal
Diagnóstico
El diagnóstico de los gliomas se realiza principalmente mediante neuroimagen, especialmente la resonancia magnética (RM), que permite identificar la localización y las características del tumor. En algunos casos, se utiliza la tomografía computarizada (TC) como complemento. Para confirmar el tipo de glioma, se requiere una biopsia o resección quirúrgica del tumor con análisis histopatológico. Hoy en día, los análisis moleculares (como la presencia de mutaciones en los genes IDH1/2, co-deleción 1p/19q y metilación del promotor MGMT) son fundamentales para clasificar adecuadamente el tumor y guiar el tratamiento.
Tratamiento
El tratamiento de los gliomas depende del tipo, grado y ubicación del tumor, así como del estado general del paciente. Las principales opciones terapéuticas incluyen:
1. Cirugía: Siempre que sea posible, se realiza una resección quirúrgica del tumor. La extirpación total mejora el pronóstico, pero no siempre es factible debido a la localización del glioma.
2. Radioterapia: Utilizada especialmente en tumores de alto grado o cuando no se puede resecar completamente el tumor.
3. Quimioterapia: El temozolomida es el fármaco más utilizado, especialmente en combinación con radioterapia. Su eficacia está relacionada con la metilación del promotor MGMT.
4. Terapias dirigidas y ensayos clínicos: Las terapias moleculares personalizadas y los tratamientos
inmunológicos se están explorando activamente como nuevas opciones para mejorar el pronóstico de los gliomas más agresivos.
Pronóstico
El pronóstico de los pacientes con gliomas varía ampliamente. Los gliomas de bajo grado pueden tener una supervivencia prolongada, especialmente si son tratados precozmente. Sin embargo, los gliomas de alto grado, como el glioblastoma, tienen una evolución más agresiva y una supervivencia media de 12 a 15 meses, a pesar del tratamiento multimodal. Los avances en el conocimiento genético y molecular están permitiendo desarrollar terapias más personalizadas que podrían mejorar significativamente estos resultados en el futuro.


Los gliomas son tumores cerebrales complejos que requieren un enfoque multidisciplinario para su manejo. Los avances recientes en genética molecular y neurooncología están revolucionando su diagnóstico y tratamiento, permitiendo una medicina más precisa y personalizada. A pesar de estos progresos, sigue siendo un reto mejorar el pronóstico de los gliomas más agresivos, lo que subraya la necesidad de continuar investigando e innovando en este campo.

Neurocirujano,

Ovni Medical Group
Torre Medicalnet B

3 RD$1.200,00

Introducción:
El cáncer de ovario ha sido históricamente uno de los tumores ginecológicos más letales. No por ser el más frecuente, sino por su capacidad de pasar desapercibido hasta etapas
• La supervivencia global a 5 años en estadio III es del 39%, y en estadio IV, apenas del 17% (SEER, 2023).
• En cambio, si es diagnosticado en estadio I, la supervivencia supera el 90%.
Sin embargo, los síntomas SÍ EXISTEN, pero no los escuchamos. Dentro de ellos están la distensión abdominal persistente, saciedad precoz, cambios urinarios, dolor pélvico, dolor lumbar, cansancio, estreñimiento o diarreas inexplicables, gases y/o pérdida de peso. No son síntomas específicos, sí, pero tampoco son normales. Nuestro GRAN reto como clínicos es dejar de normalizar lo que molesta y empezar a investigar lo que se repite.

¿Estamos diagnosticando tarde porque estamos escuchando mal?
El retraso diagnóstico no siempre es culpa del paciente. Muchas veces es el sistema y sus médicos quienes minimizan las señales de alarma.
• ¿Cuántas veces una mujer con distensión abdominal se va a casa con diagnóstico de colitis?
• ¿Cuántas veces los antecedentes familiares se pasan por alto?
• ¿Cuántas veces una paciente se salta su revisión anual ginecológica de rutina solo porque se siente bien o no tiene quejas?
• Se estima que una mujer con cáncer de ovario consulta a su médico entre 3 y 5 veces antes de obtener un diagnóstico correcto (BMJ, 2012).
• Hasta un 21% de los casos se diagnostican en servicios de urgencias.
La historia clínica enfocada, el examen físico dirigido y el uso apropiado del ultrasonido transvaginal y marcadores tumorales como el CA-125 son herramientas a nuestro alcance. No son perfectas, pero pueden ser el punto de partida para salvar una vida. Si se sospecha cáncer de ovario por ultrasonografía, se deben indicar pruebas adicionales como una RMN de la pelvis, una TAC del abdomen/ pelvis y/o análisis de sangre. Si se detecta cáncer, su médico podría utilizar exploraciones por TC, RMN o PET para determinar la extensión y tamaño del tumor, y si se ha diseminado.
Genética: la puerta que aún no todos queremos abrir
Los genes BRCA1 y BRCA2 no solo importan en el cáncer de mama.
• El riesgo acumulado de desarrollar cáncer de ovario a los 70 años es del 39–44% para BRCA1 y del 11–17% para BRCA2.
• Entre el 15–20% de los cánceres de ovario tienen una base hereditaria, y solo una fracción de estas mujeres son derivadas oportunamente para asesoría genética (NCCN Guides, 2024).
Incorporar el tamizaje genético en poblaciones seleccionadas debe dejar de ser inalcanzable. Debe convertirse en parte de los protocolos internacionales. Y nosotros, como médicos, debemos liderar ese cambio.
¿Y la prevención? Hablemos claro: NO existe aún. Pero SÍ hay acciones.
A diferencia del cáncer de cuello uterino, no tenemos una herramienta eficaz de tamizaje poblacional para el cáncer de ovario. Pero sí tenemos posibilidades de reducir el riesgo:

• El uso de anticonceptivos orales por más de 5 años puede reducir el riesgo en hasta un 50%.
• La ligadura tubárica reduce el riesgo en un 30–40%.
• La salpingooforectomía profiláctica en mujeres con mutaciones BRCA reduce el riesgo de cáncer de ovario en más del 80–90% y también disminuye el riesgo de cáncer de mama si se realiza antes de la menopausia.
Estas decisiones deben basarse en una evaluación individualizada, ética y centrada en el paciente.
El tratamiento dependerá de si el cáncer se encuentra confinado al ovario o la pelvis, o diseminado a otras partes del cuerpo. Las opciones incluyen cirugía y terapias sistémicas, incluyendo la quimioterapia, la inmunoterapia y la radioterapia.
Conclusión: el silencio mata y la sospecha salva
Como profesionales, tenemos la responsabilidad de ser la voz de nuestros pacientes cuando sus cuerpos hablan en susurros. Sospechar a tiempo, actuar con decisión y abogar por el acceso a la genética, la imagenología especializada y la educación puede
cambiar el rumbo de una enfermedad que, en muchos casos, sigue cobrando vidas sin hacer ruido.
¿Qué sigue?
Que dejemos de esperar síntomas “graves” para actuar.
Que eduquemos a nuestros pacientes y a nuestros colegas.
Que el cáncer de ovario deje de ser silencioso, porque nosotros decidimos hacer más ruido.

Dra. Patricia M. Polanco
• Gineco-Endocrinóloga
• Directora médica de Salud Femenina
• Propietaria de RADNET Centro de Imágenes

Frecuencia e incidencias
Según estudios recientes:
Los tumores vertebrales primarios representan menos del 10% de los tumores espinales, mientras las metástasis óseas en la columna vertebral son más frecuentes. Entre el 30% y 70% de los pacientes con cáncer avanzado desarrollan metástasis en los huesos y de estos, entre 70% y 90% comprometen la columna.
Las metástasis en la columna provienen principalmente de tumores primarios de mama (70%), pulmón (60%) y próstata (65%), seguidos por el cáncer de riñón y de tiroides. La mayoría de estas metástasis ocurren en las vértebras torácicas (70%), seguidas de las lumbares (20%) y cervicales (10%).
En fases iniciales, los tumores vertebrales pueden no causar síntomas. A medida que crecen, los más comunes son: dolor de espalda persistente, que empeora al acostarse, puede estar o no irradiado hacia los brazos o piernas, acompañado de hormigueo, debilidad o pérdida de sensibilidad. En la medida que compromete la medula o los nervios, generan dificultad para caminar o mantener el equilibrio, llegando a perder el control de los esfínteres; también, deformidad visible de la columna.

tumores en tejidos blandos.
Tomografía computarizada (TC): muestra daño en los huesos.
Gammagrafía ósea: identifica actividad tumoral.
Biopsia: confirma el tipo de tumor (benigno o maligno).
También se realizan estudios para identificar el tumor primario en casos de metástasis.

El tratamiento depende del tipo de tumor primario, su tamaño, síntomas y estado del paciente. Las principales alternativas incluyen:
Observación
Si el tumor es pequeño, benigno y asintomático, puede optarse por control con imágenes periódicas.
Cirugía
Indispensable cuando hay compresión de la médula espinal, dolor de severa intensidad o riesgo de fractura o inestabilidad espinal.
Ventajas comprobadas:
Alivia la compresión nerviosa.
Estabiliza la columna.
Disminuye el dolor y mejora la movilidad.
Hoy existen varias técnicas quirúrgicas, las alternativas van desde la cirugía abierta a procedimientos de mínima invasión, como la vertebroplastia,
cifoplastia o el uso sistemas de fijación pediculares percutáneos, más recientemente se emplea la radiofrecuencia, la termoablación por laser
Radiocirugía Estereotáctica (SRS) Es una técnica de alta precisión que entrega radiación concentrada sobre el tumor sin dañar tejidos sanos circundante. Ofrece un 92% de control local del tumor al año y menos del 10% de recaídas si se aplica una sola dosis alta (24 Gy).
Radioterapia Convencional
Menos precisa que la SRS, pero útil cuando la radiocirugía no está disponible o se trata de tumores muy extensos o radio resistentes
Quimioterapia
El avance de la quimioterapia hoy día es importante. En cáncer de pulmón de células pequeñas, es capaz de reducir el tumor en el 70–80% de los casos. Su eficacia varía según el tipo de tumor y la presencia o no de mutaciones genéticas.
Terapias Dirigidas
Fármacos que actúan sobre características específicas de las células tumorales con menos efectos secundarios, como son la inmunoterapia, la hormonoterapia.

Cuidados Paliativos
Incluyen analgésicos, fisioterapia y apoyo psicológico para mantener la calidad de vida de los pacientes.
PRONÓSTICO Y SEGUIMIENTO
Los tumores benignos tienen excelente pronóstico si se detectan a tiempo, mientras que, en las metástasis, se busca controlar el dolor, preservar la función neurológica y extender la supervivencia y calidad de vida. El seguimiento con imágenes (RM o TC) es clave para evaluar la evolución y detectar oportunamente las recurrencias. Los tumores vertebrales pueden ser graves, pero los avances actuales permiten un mejor manejo y por ende, mejoría en la expectativa y calidad de vida de los pacientes.

Neurocirujano

La enfermedad ha sido desde siempre un territorio fértil para la literatura. Desde la peste que arrasa ciudades en Decamerón o La peste de Camus, hasta la tuberculosis romántica del siglo XIX en La dama de las camelias de Alexandre Dumas, o la locura en la narrativa modernista, las dolencias del cuerpo se entrelazan con las dolencias del alma, revelando la fragilidad humana. Pero entre todas las enfermedades, el cáncer ocupa un lugar particular en el imaginario literario contemporáneo: no solo como mal físico, sino como símbolo de decadencia, de lo innombrable, del dolor sin redención. Este padecimiento se ha convertido en una herida narrativa, una herida que no solo sangra, sino que exige ser contada.
La literatura del yo enfermo se ha expandido en las últimas décadas, y en ella el cáncer aparece como una forma de autoconocimiento forzado. Uno de los textos fundamentales es La enfermedad y sus metáforas de Susan Sontag, publicado en 1978. Aunque no es una novela, su ensayo analiza críticamente cómo el cáncer ha sido metaforizado en la cultura y cómo estas metáforas agravan el sufrimiento del paciente. Sontag, diagnosticada con cáncer de mama, denuncia la carga simbólica que la sociedad impone sobre la enfermedad: la idea de que el cáncer es una forma de castigo, una autodestrucción inconsciente, una señal de debilidad emocional. Ella aboga por despojar al cáncer de su
Sin embargo, otras autoras han asumido una visión más íntima y literaria de la experiencia. Annie Ernaux, en El acontecimiento y El uso de la foto, y Audre Lorde, en The Cancer Journals, convierten el cuerpo enfermo en escritura. Lorde, por ejemplo, escribe desde su experiencia como mujer negra con cáncer de mama y reconstruye su cuerpo narrativo a través de la resistencia y la memoria. El cáncer, en estos textos, es al mismo tiempo herida y lenguaje, límite y origen.


En cambio, en la novela contemporánea La ridícula idea de no volver a verte de Rosa Montero, el cáncer se presenta en paralelo con la biografía de Marie Curie. Montero reflexiona sobre la muerte de su esposo, víctima de cáncer, y entrelaza su duelo con el de Curie, construyendo una suerte de ensayo narrativo donde el cáncer deviene pregunta ontológica: ¿cómo vivir con la conciencia de lo irreversible? Asimismo, en obras como Bajo la misma estrella de John Green, el cáncer adolescente se transforma en dispositivo narrativo de amor, tragedia y sentido. Se corre el riesgo de estetizar la enfermedad, pero también se
humaniza su experiencia. La muerte no es un final repentino, sino un trayecto lleno de diálogos filosóficos, esperanzas rotas y belleza inminente.
El cáncer también ha sido símbolo del mal invisible en la poesía. La poeta estadounidense Jane Kenyon, fallecida de leucemia, escribió versos donde la enfermedad aparece como una sombra persistente que deforma
disruptiva, una narración que no permite planear el final, sino que lo va reescribiendo a medida que avanza.
Además, el cáncer impone un cambio en la perspectiva narrativa. Muchas veces, el narrador se convierte en paciente, o el protagonista pierde su agencia. Las novelas de Paul Auster y Philip Roth exploran esa impotencia: en Everyman o Patrimony, Roth
asoma a la nada, y que a veces, solo a veces, encuentra belleza en el acto de nombrar el dolor.
El cáncer en la literatura no es un simple tema: es una forma de narrar la fragilidad, la transformación y la urgencia de vivir. A través del cáncer, los escritores han explorado los límites del lenguaje, del cuerpo, del tiempo y del sentido. En cada obra que lo aborda, el cáncer aparece como una herida que sangra tinta, como una metáfora que, lejos de ser decorativa, es vital, desgarradora y necesaria.

Comprender cómo el cáncer ha sido representado en la literatura es también un acto de resistencia: contra el silencio, contra la estigmatización, contra la negación de lo humano. Es una forma de mirar al abismo y escribir desde allí.

Dr. Juan Carlos Toral
Pediatra neonatólogo

Cuando nos referimos a neoplasias en niños, los tumores primarios del sistema nervioso ocupan el segundo lugar, siendo la leucemia el más frecuente. La incidencia de los tumores cerebrales en pacientes de 0 a 19 años es de 3.3 a 4.5 casos por cada 100,000 habitantes.
Ubicada en la parte central del cerebro, se encuentra una glándula neuroendocrina llamada glándula pineal o epífisis, cuya función principal es producir melatonina, una hormona esencial en la regulación del ciclo vigilia-sueño, y liberarla hacia el torrente sanguíneo.
En esta zona del cerebro puede ocurrir esta formación anormal de células o tumores, y representan del 3 al 11 % de los tumores cerebrales en edad pediátrica, y menos del 1 % en la población adulta.
Esta región pineal es una de las áreas neoplásicas más complejas del cerebro, tanto por su ubicación anatómica como por su gran diversidad histológica. Los tumores del parénquima pineal
(ej. pineocitomas y pineoblastomas) y los tumores de células germinales (ej. germinomas) representan los tipos de tumores epifisarios más frecuentes.
La glándula pineal se encuentra en proximidad con importantes estructuras cerebrales, como el cuerpo calloso — vital en la coordinación entre ambos hemisferios cerebrales—, los colículos inferior y superior —involucrados en el procesamiento auditivo y control ocular, respectivamente—, el acueducto de Silvio — crucial para el flujo del líquido cefalorraquídeo—, entre otras.
Es por esto que cualquier tumor en esta región podría comprimir cualquiera de estas estructuras, produciendo entonces distintos

cuadros clínicos. Podría interrumpir el flujo del líquido cefalorraquídeo, produciendo así aumento de la presión dentro del cerebro o hidrocefalia, con síntomas como náuseas, vómitos, dolores de cabeza e incluso convulsiones. Puede afectar el techo del mesencéfalo, donde se encuentran los colículos superiores, provocando visión doble por alteración de los movimientos oculares. También podría haber efecto del tumor sobre el hipotálamo, provocando disfunciones endocrinológicas como pubertad precoz, diabetes insípida y alteración del crecimiento.
El tratamiento de estos tumores, por lo general, incluye una combinación de resección quirúrgica, radioterapia y quimioterapia. Su pronóstico dependerá mucho de la histología del tumor. Por ejemplo, los pineocitomas no suelen hacer metástasis y tienen un pronóstico favorable, al igual que los germinomas. En cambio, los pineoblastomas son extremadamente agresivos y tienen mal pronóstico.

A Tomografía axial computarizada demostrando neoplasia de la glándula pineal con calcificación central. B Resonancia magnética nuclear demostrando tumor de la glándula pineal
Fotografía recuperada el 02 de junio, 2025. Disponible en: Primary neuroendocrine tumor of the pineal gland: a case report | BMC Neurology | Full Text (biomedcentral.com)

Neuróloga pediatra

Referencias bibliográficas:
(1) Swaiman, K. Neurología Pediátrica: Principios y práctica (6ta Edición). Minneapolis, Minnesota, Estados Unidos: Elsevier. 2017.
(2) Tumores pineales. Recuperado el 02 de junio de 2025. Disponible en: Pineal Tumors: Practice
Essentials, Anatomy and Physiology, Pathophysiology (medscape.com)

No siempre es necesario operar en casos de cáncer de mama. La cirugía es uno de los tratamientos principales, pero la decisión depende de varios factores, como el tipo y la etapa del cáncer, la salud general de la paciente y sus preferencias.
En algunos casos se pueden utilizar tratamientos como radioterapia, quimioterapia o la terapia hormonal en lugar de la cirugía, o como parte del tratamiento antes o después de la operación.
Cada caso es único y debe ser evaluado por un equipo de médicos especializados.
En casos de cáncer de mama en etapas tempranas, la cirugía es el pilar principal. Sin embargo, no siempre es así. Se puede presentar un tumor irresecable o en formas avanzadas (con metástasis o ganglios positivos).
Hace más de 30 años usamos terapia neoadyuvante con quimioterapia antes de plantearnos la cirugía en candidatas elegibles para intentar curarlas con cirugía. Estas pacientes son las que genotípicamente son llamadas triples negativas (con
receptores hormonales negativos y Her-2neu negativos).
La quimioterapia preoperatoria en estos casos puede reducir tumores grandes inoperables a poder someterse a mastectomía o cirugía preservando la mama, y así contribuir a una mejor terapia sistémica.
En la actualidad, los datos nos reportan que el 60 % de las pacientes triple negativas pueden tener respuesta patológica completa con este protocolo (quimioterapia prequirúrgica).
En relación con la cirugía conservadora de la mama (preservándola) y la mastectomía (amputando la mama), es importante establecer que siempre que se preserva la mama en pacientes con cáncer temprano, es imperativa la radioterapia en la mama afectada como tratamiento adyuvante posquirúrgico.
El tratamiento adyuvante (poscirugía) se establece con el propósito de tratar micrometástasis (células que se han movido a los ganglios linfáticos regionales, pero sin lesión demostrable en otros órganos). El tratamiento adyuvante se realiza a base de radioterapia y tratamientos sistémicos que incluyen una
gran variedad de quimioterápicos, terapia hormonal y agentes biológicos.


¿Qué hacer con las pacientes que se presentan con cáncer metastásico?
moderna se ha hecho más efectiva, intactos y metástasis pueden tener residual metastásica después modifican la sobrevida, de la enfermedad.
¿Qué es el y cómo tratarlo?
Se define como una condición en la que las células anormales se encuentran en los conductos de la mama, pero no han invadido el tejido circundante. Es una etapa temprana del cáncer de mama y, aunque no se ha diseminado, puede aumentar el riesgo de desarrollar un cáncer invasivo en el futuro. Su tratamiento varía dependiendo de las características específicas del caso.
Las opciones incluyen:
1. Cirugía conservadora de la mama: solo se extirpa el área afectada (lumpectomía).
2. Mastectomía: puede ser necesaria la extirpación completa de la mama para casos extensos.
3. Radioterapia: puede ser utilizada después de la lumpectomía para eliminar cualquier célula cancerosa residual.
4. Terapia hormonal: en ciertos casos se utiliza para reducir el riesgo de recurrencia. Entre los medicamentos más usados están el tamoxifeno, el raloxifeno y el anastrozol.
Cada caso debe ser personalizado.



El carcinoma de células escamosas es el tipo de cáncer más común en la lengua,yes uno de los más predominantes a nivel de cabezaycuello.Este cáncer se origina en las células planasydelgadas que recubren la superficie de la lengua. Aunque ningún diagnóstico de cáncer resulta libre de preocupaciones, se ha demostrado que la detección precoz y los tratamientos modernos han mejorado significativamente los resultados. Para poder asegurar una detección oportuna, es necesario entender los factores que pueden predisponernos al desarrollo de este padecimiento, así como signos y síntomas de alerta, y también entender las opciones de tratamiento disponibles en la actualidad.
Las células escamosas cubren la superficie de muchas partes del cuerpo, entre ellas incluida la lengua. Cuando estas células crecen sin control, forman lo que conocemos como un tumor, y se denomina
carcinomade células escamosas. En la lengua, estetipo de cáncer puede afectar tanto a la lengua oral, que es la porción que compone los dos tercios anteriores, como a la base de la lengua, que se encuentra próxima a la garganta. Conociendo esto, cabe destacar que este tipo de cáncer puede comportarse de forma diferente en función de su localización a nivel de la lengua. Como en muchas otras enfermedades, uno de los factores más importantes es la edad, pues este cáncer es más frecuente en personas mayores de 50 años, pero también puede afectar a personas más jóvenes, sobre todo si existen determinados factores de riesgo de los que hablaremos a continuación.

Varios factores relacionados con el estilo de vida y la salud pueden aumentar el riesgo de desarrollar carcinoma de células escamosas en lengua:
• Consumo de tabaco: Fumar cigarrillos, puros o consumir tabaco de mascar es uno de los factores de riesgo más importantes.
• Consumo de alcohol: El consumo frecuente y excesivo de alcohol puede aumentar aún más el riesgo, especialmente cuando se combina con el tabaco.
• Virus del papiloma humano (VPH): La infección por cepas de alto riesgo del VPH, en particular el VPH-16, se ha relacionado con cánceres en la base de la lengua.
• Mala higiene bucal e inflamación crónica: Un cuidado dental deficiente y una inflamación prolongada pueden contribuir al desarrollo.
• Antecedentes familiares o predisposición genética: Los factores hereditarios también pueden influir, aunque no está muy clara la influencia para este tipo.

Signos y síntomas
En fase inicial, frecuentemente no causa síntomas perceptibles. Sin embargo, a medida que se desarrolla, los pacientes pueden experimentar algunas o todas las siguientes:
• Una llaga o úlcera persistente en la lengua que no se cura.
• Dolor o molestias en la lengua o la boca.
• Un bulto o engrosamiento en la lengua.
• Dificultad para masticar, traga o hablar.
• Sangrado inexplicable de la lengua.
• Pérdida de sensación u hormigueo en la lengua.
Algunas de estas señales pueden ser transitorias y ocasionadas por otros factores, pero si se experimenta alguno de estos síntomas durante más de dos semanas, es esencial que acuda a ayuda profesional para ser evaluado.
Luego de que se acude a un profesional, y tras realizar historia clínica y examen físico, se pueden realizar algunos estudios para confirmar el diagnóstico:
• Biopsia: donde se toma una pequeña muestra de tejido para detectar células cancerosas.
• Endoscopia: donde se utiliza una cámara para examinar la garganta y las vías respiratorias superiores, en los casos donde se sospecha una lesión cercana a la base de la lengua. Los estadios van del I (temprano, localizado) al IV (avanzado, potencialmente extendido a los ganglios linfáticos u otras zonas).
El tratamiento dependerá del tamaño, la localización y el estadio del cáncer:
• Cirugía: el método principal para extirpar un tumor, especialmente en estadios tempranos. A veces puede ser necesario extirpar parte de la lengua (glosectomía), con opciones reconstructivas disponibles.
• Radioterapia: a menudo se utiliza después de la cirugía o como tratamiento primario en los casos iniciales.
• Quimioterapia: puede utilizarse en casos avanzados, a menudo en combinación con radioterapia.
La recuperación depende de la fase en que se encuentre el cáncer en el momento del diagnóstico y de la respuesta al tratamiento. Muchas personas se recuperan bien, sobre todo cuando el cáncer se detecta oportunamente. Luego del fin del tratamiento, el seguimiento es fundamental para vigilar las recidivas y controlar los efectos secundarios, como la dificultad para hablar o comer. En algunos casos, cuando se realiza algún procedimiento más invasivo, es necesario un proceso de rehabilitación, donde se puede incluir logopedia y asesoramiento nutricional para ayudar a recuperar las funciones cotidianas y mejorar la calidad de vida.



Reducir el riesgo
Con la finalidad de reducir las posibilidades de este cáncer, es importante evitar el tabaco y limitar el consumo de alcohol, así como asegurarse de practicar una buena higiene bucal y someterse a revisiones dentales periódicas. Para individuos con capacidad de acceder a vacunación, se recomienda la vacuna contra el VPH para evitar este y otros tipos de cánceres.
Estar informado sobre el carcinoma escamocelular de lengua puede permitirnos tomar medidas a tiempo. Aunque un diagnóstico de cáncer es desagradable, los avances en ciencia y la atención personalizada han mejorado los resultados para muchas personas con carcinoma escamoso de lengua. Con cualquier problema persistente en la boca o la lengua, es importante acudir a un profesional y evitar grandes consecuencias.
Referencias
Miguelanez-Medran, B., Pozo-Kreilinger, J., Cebrian-Carretero, J., Martinez-Garcia, M., & Lopez-Sanchez, A. (2019). Oral squamous cell carcinoma of tongue: Histological risk assessment. A pilot study. Medicina Oral, Patología Oral Y Cirugía Bucal, 0. https://doi. org/10.4317/medoral.23011
Nokovitch, L., Maquet, C., Crampon, F., Taihi, I., Roussel, L., Obongo, R., Virard, F., Fervers, B., & Deneuve, S. (2023). Oral cavity squamous cell carcinoma risk Factors: state of the art. Journal of Clinical Medicine, 12(9), 3264. https://doi.org/10.3390/jcm12093264
Okubo, M., Iwai, T., Nakashima, H., Koizumi, T., Oguri, S., Hirota, M., Mitsudo, K., & Tohnai, I. (2016). Squamous cell carcinoma of the tongue dorsum: Incidence and treatment considerations. Indian Journal of Otolaryngology and Head & Neck Surgery, 69(1), 6–10. https://doi.org/10.1007/s12070016-0979-z
Yosefof, E., Hilly, O., Stern, S., Bachar, G., Shpitzer, T., & Mizrachi, A. (2020). Squamous cell carcinoma of the oral tongue: Distinct epidemiological profile disease. Head & Neck, 42(9), 2316–2320. https://doi.org/10.1002/ hed.26177

Dra. Norka Ramírez Medicalnet A, Suite 303 809-621-8282
Odontóloga, Estética Dental, Rehabilitación Bucal e Implantes
Según la OMS El cáncer de mama es la neoplasia más común entre las mujeres a nivel mundial y una de las principales causas de mortalidad femenina. Afecta a mujeres en todas las edades, razas y niveles socioeconómicos.
La detección temprana del cáncer de mama mediante pruebas de imágenes es clave para mejorar la supervivencia y reducir significativamente la morbimortalidad asociada.
Actualmente, la mamografía digital, la Tomosíntesis digital y la Sonomamografía (ecografía mamaria) conforman el pilar de estrategias de screening y diagnóstico.


La mamografía digital
Consiste en la utilización de rayos x para producir imágenes bidimensionales de la mama. Permite detectar lesiones hasta dos años antes de que sean palpables. Esta técnica ha sido fundamental en programas de cribado poblacional, contribuyendo a una disminución
significativa de la mortalidad.contra este padecimiento. La información y la prevención son herramientas esenciales para reducir su impacto y mejorar la calidad de vida de quienes lo enfrentan.
No obstante, su sensibilidad disminuye en mujeres con tejido mamario denso, lo que puede llevar a falsos negativos y diagnósticos tardíos. Además, en algunos casos la superposición de tejidos puede dificultar la detección de lesiones pequeñas o sutiles.

La Tomosíntesis digital
Es otra técnica de imágenes, similar a la mamografía, pero que produce múltiples cortes del tejido mamario, obteniendo una imagen tridimensional. Esta técnica permite una mejor visualización de las estructuras internas de la mama, reduciendo el efecto de superposición
de tejidos y mejorando la calidad visual de lesiones pequeñas en el 3D. Conlleva mayor radiación, pero en límites permitidos, mayor costo y necesidad de equipos y formación profesional para evitar sobrediagnósticos.
La mamografía digital y la Tomosíntesis se pueden realizar juntas en una sola compresión de la mama, lo que aumenta la comodidad del paciente y la calidad diagnóstica. Diversos estudios han demostrado que la combinación de Tomosíntesis con mamografía digital aumenta la tasa de detección del cáncer y puede reducir la tasa de indicación de estudios adicionales, especialmente en el caso de lesiones no neoplásicas.



publicado en la revista Radiology: Artificial Intelligence sugiere que el uso de inteligencia artificial en la mamografía digital con Tomosíntesis mejora la precisión del cribado secuencial, permitiendo una detección más temprana y aún más precisa de anomalías sospechosas.
Es una técnica que utiliza ultrasonido para la evaluación de la mama, ya sea como estudio primario o complementario, detectando y caracterizando lesiones, sobre todo en mujeres jóvenes o mujeres con mamas densas e implantes mamarios. Es un estudio sin radiación, operador dependiente con costo accesible e ideal para guiar biopsias. Es limitado para la evaluación de microcalcificaciones y asimetrías de tejido.
No hay una respuesta universal. Depende del contexto y del escenario. Se tomará siempre en consideración la edad del paciente, sus antecedentes y si hay masas palpables en la evaluación clínica.
Podemos concluir que estas técnicas se complementan y que, para un cribado eficaz, La Tomosíntesis digital representa una evolución significativa, especialmente en mujeres con tejido mamario denso. Si bien la mamografía digital sigue siendo una herramienta valiosa, la incorporación de la Tomosíntesis y tecnologías emergentes como la inteligencia artificial podrían redefinir las estrategias de cribado en un futuro cercano.
Combinar la mamografía o la Tomosíntesis con la Sonomamografía ofrece mayor sensibilidad y especificidad, superando lo que nos brinda cada técnica por separado.
Dra. Carolina Aquino Smester Imágenes Médicas
Especialista en Imágenes diagnósticas, Radiología general/ Sonografía
Dra. Jacqueline Abreu S.
Sonografía general y Elastografia
Dr. Ramiro Díaz Primera
Especialista en Medicina materno fetal.
Dr. José De Lancer
Especialista en Medicina materno fetal.
Dr. Julio Warden
Especialista en imágenes diagnósticas y Mapeo Avanzado de Endometriosis.

Medicalnet A info@imedec.com
Teléfono y WhatsApp: 809.566.8744

La inteligencia artificial (IA), especialmente mediante sistemas de detección asistida por computadora (CADe) y diagnóstico asistido (CADx), ha demostrado mejorar significativamente la eficacia de las técnicas endoscópicas en el ámbito gastrointestinal. Este artículo analiza su aplicabilidad clínica, evidencia actual y desafíos presentes.
El Centro de Gastroenterología Avanzada (CGA) fue el primer centro de endoscopia con contar con esa técnica en toda Latinoamérica, la misma ha estado en CGA desde enero del 2023, lo que nos ha permitido ser los pioneros de esta tecnología en el país.
Colonoscopia asistida por IA (CADe)
El cáncer de colon es la segunda causa de muerte por cáncer tanto en hombre como en mujeres, y se calcula que va a ser la primera causa de muerte por cáncer para el año 2030 en personas de menos de 45 anos, por ello todas las guías de las sociedades científicas de gastroenterología o de cáncer recomienda la misma a todas las personas que hayan cumplido 45 años.
Hoy existen múltiples equipos de IA para la detección de pólipos.
La colonoscopia es la mejor herramienta que existe para la prevención del cáncer de colon, pero su eficacia esta directamente relacionada a la capacidad que tiene el endoscopista en detectar las lesiones precancerosas, llamadas pólipos adenomatosos.


La colonoscopia asistida por IA tiene la capacidad de detectar los pólipos y alertar al endoscopista su presencia, actuando como un tercer ojo o un copilot, con la ventaja que la IA no se distrae ni se cansa.

Meta-análisis recientes muestran que los sistemas CADe aumentan la tasa de detección de adenomas (ADR) hasta en un 24% y los adenomas por colonoscopia (APC) hasta en un 39%. También se ha demostrado una reducción significativa en la tasa de pólipos omitidos en estudios prospectivos. El principal beneficio se observa en pólipos pequeños (<5mm), sin incremento confirmado en adenomas avanzados.
Diagnóstico de cáncer gástrico y esofágico con IA (CADx)
Las Neoplasias de Esófago y del Estomago también representan un problema de salud frecuente y devastador, y son una causa mayor de muerte por cáncer en el mundo, al igual que con el cáncer de colon, la gastroscopía es la mayor herramienta para la detección de las lesiones premalignas o la detección temprana del cáncer y con ello reducir la aparición de los mismos y sobre todo prevenir la muerte por cáncer del esófago y del estomago.


Los sistemas basados en redes neuronales convolucionales (CNN) permiten identificar lesiones precoces con sensibilidad comparable a expertos humanos. Estudios multicéntricos evidencian reducción de lesiones omitidas y aumento de precisión diagnóstica, lesiones precursoras de cáncer y ser removidas a través de la misma endoscopia y así prevenir el cáncer gástrico y esofágico o su detección temprana de forma que también pueda ser tratada y curados de manera no invasiva.

Ventajas operacionales y estructurales
El flujo de trabajo con IA en tiempo real permite integrar CADe/ CADx durante la endoscopía sin aumento en el tiempo promedio del procedimiento. Estudios económicos demuestran que esta tecnología no solo salva vidas sino que también ahorra recursos a los sistemas de salud.
Desafíos y perspectivas a futuro
Aunque esta tecnología ha mostrado una mejoría en la detección de lesiones tempranas todavía hay espacio para mejorar no solo en la detección sino también la caracterización de las lesiones, en la predicción de la extension de las mismas y además la IA nos va ayudar en múltiples otros factores que
mejoraran la calidad y la eficiencia de la endoscopia como herramienta para la prevención y tratamiento de las neoplasia gastrointestinales.
Persisten desafíos en validación clínica, falsos positivos y protección de datos. Es necesaria una regulación ética robusta para su adopción segura.
Conclusión
La IA ofrece mejoras clínicas claras en endoscopía digestiva. Con entrenamiento adecuado y regulación apropiada, se perfila como una herramienta esencial en la práctica médica moderna.

Gastroenterólogo, Director Médico en CGA, Director Médico Unidad Endoscopía
Medicalnet A, Suite 602 (809)-567-1815


En Referencia Laboratorio
Clínico nos hemos enfocado en lograr una solución diagnóstica única en el país, con la integración de datos provenientes de múltiples disciplinas que permiten una visión más profunda y granular del cáncer; ya que los modelos basados en múltiples variables diagnósticas ofrecen un mayor rendimiento predictivo, optimizando la selección de terapias y personalizando los tratamientos de manera más efectiva.
Cuando a una persona se le menciona un diagnóstico asociado a cáncer, como leucemIa, linfoma, entre otras; una de las primeras preguntas suele ser: ¿Cómo se llega a ese diagnóstico? y ¿cómo saben los médicos si el tratamiento está funcionando? Para responder a estas inquietudes, es importante conocer algunas pruebas clínicas y estudios de patología que, aunque suenen complejos, cumplen un papel fundamental en la lucha contra el cáncer.
En este artículo, te explicamos tres herramientas clave utilizadas por los médicos especialistas: la biopsia de médula ósea, la inmunohistoquímica y la citometría de flujo.
Biopsia de médula ósea: mirando donde nacen las células de la sangre.
Cuando se sospecha de una enfermedad en la sangre, una de las primeras pruebas referidas por los médicos es una biopsia de médula ósea.

2007 Terese Winslow LLC U.S Govt. has certain rights
La biopsia de médula ósea es una herramienta diagnóstica y pronóstica fundamental en hematología y oncología, utilizada para evaluar la celularidad, arquitectura e infiltración de enfermedades en la médula ósea. Es clave para el diagnóstico de neoplasias hematológicas (leucemias, linfomas, mieloma múltiple, neoplasias mieloproliferativas),


la estadificación del cáncer y la evaluación de síndromes de falla medular como la anemia aplásica y los síndromes mielodisplásicos. También permite detectar infecciones (como tuberculosis e histoplasmosis), trastornos de almacenamiento (como la enfermedad de Gaucher) y enfermedades granulomatosas. Además, es esencial para el monitoreo de la respuesta al tratamiento, incluida la enfermedad mínima residual (EMR) en leucemia, y para estudios citogenéticos y moleculares en la estratificación del riesgo genético.
Inmunohistoquímica: “tintes inteligentes” para identificar las células.
Una vez obtenida una muestra, los médicos no solo observan su forma, sino que también buscan marcadores en las células. Para eso utilizan una técnica llamada inmunohistoquímica (o IHC, por sus siglas en inglés).
La inmunohistoquímica (IHC) es una técnica esencial en el diagnóstico del cáncer, ya que permite identificar con precisión el tipo de tumor y su comportamiento. Se basa en el uso de anticuerpos que detectan proteínas específicas en las células, ayudando a confirmar el origen de la enfermedad y diferenciar entre tipos similares, como linfomas de distintos subtipos o tumores poco diferenciados. Esta herramienta es clave en enfermedades como el linfoma de Hodgkin, leucemias linfoblásticas (B y T), linfoma de Burkitt, tumores cerebrales, sarcomas, neuroblastomas y cánceres pediátricos como el hepatoblastoma.
La IHC en las biopsias de médula ósea es fundamental para diagnosticar y clasificar neoplasias hematológicas, diferenciando neoplasias mieloides vs. linfoides, e identificando linfomas (CD20, CD3), discrasias de células plasmáticas (CD138, kappa/lambda) y tumores metastásicos (citoqueratinas, PSA, S100).
Además de permitir un diagnóstico más exacto, la IHC ayuda a evaluar la agresividad del tumor mediante marcadores de proliferación como Ki-67, detectar si aún quedan células cancerosas tras el tratamiento (enfermedad mínima residual), y guiar la elección de terapias personalizadas, como medicamentos dirigidos a proteínas específicas (por ejemplo, ALK o PD-L1). También permite distinguir entre un cáncer primario y una metástasis, lo cual es clave para el tratamiento adecuado. En resumen, la inmunohistoquímica es una herramienta indispensable en la medicina moderna que permite a los médicos tomar decisiones más informadas y precisas para el beneficio del paciente.

Citometría
tecnología para detectar hasta la última célula enferma.
Las leucemias, linfomas y mieloma son consecuencia de una multiplicación celular anómala y descontrolada de células hematológicas clonales. Estas células anormales proliferan y dejan de llevar a cabo su función normal. Al no morir al mismo ritmo que las células normales, se acumulan en la médula ósea, en los ganglios linfáticos o en otros tejidos en los que van multiplicándose. A medida que aumenta el número de células en la médula ósea, las células normales quedan desplazadas por las cancerosas, inhibiéndose la producción de las primeras.
Hace dos años, Referencia introdujo al país la metodología de citometría de flujo, fundamental en las neoplasias hematológicas para el
La detección de enfermedad mínima residual (EMR) por citometría de flujo es una herramienta sensible para identificar células leucémicas o linfoides residuales después del tratamiento. Permite la detección temprana de recaídas, estratificación del riesgo y evaluación del pronóstico, ya que la EMR positiva se asocia con mayores tasas de recaída. También ayuda a monitorizar la eficacia del tratamiento y a guiar decisiones terapéuticas, como intensificar la terapia o considerar un trasplante de médula ósea temprano.
La citometría de flujo es fundamental para la inmunofenotipificación de leucemias agudas, ya que permite asignar con precisión el linaje celular (mieloide vs. linfocítico B o T), realizar la subclasificación e identificar casos de leucemia aguda de fenotipo mixto.
Saber que existe tecnología disponible en nuestro país, capaz de detectar hasta las células más pequeñas de la enfermedad oncológica, y que permiten al equipo médico elegir la terapia más adecuada, permite la toma de decisiones más segura y con menor tiempo de espera.
Av. Luperón No. 3, esquina mirador Sur, Zona Industrial de Herrera.

(809) 221-5545
@labreferencia
www.labreferencia.com

INTRODUCCIÓN
En el 2022, se reportaron alrededor de 660.000 nuevos casos de cáncer de cérvix y alrededor de 350.000 muertes en todo el mundo, lo que lo convierte en el cuarto cáncer más común en las mujeres
a nivel mundial, y el segundo en la República Dominicana, con un estimado de 1.074 casos diagnosticados cada año y 714 muertes debido a la enfermedad.
CAUSA: VIRUS DE PAPILOMA HUMANO
El virus del papiloma humano (VPH) es un virus ADN que pertenece a la familia Papillomaviridae. Se dirige específicamente a las células epiteliales y a las membranas mucosas. Se han identificado más de 200 cepas de VPH y casi todas las personas sexualmente activas se ponen en contacto con el virus en algún momento de su vida, normalmente sin síntomas. La mayoría de las lesiones desaparecen
El frotis de Papanicolaou es un método citológico de cribado utilizado principalmente para la detección precoz de procesos premalignos y malignos en el epitelio cervical. Desarrollada por el Dr. Georgios Papanicolaou a principios del siglo XX, la prueba consiste en la recogida y evaluación microscópica
al cabo de 6-12 meses debido a la intervención inmunológica.
Los tipos oncogénicos del VPH son la causa principal de las lesiones precancerosas y cancerosas del cérvix y aproximadamente el 70% de todos los casos de cáncer son atribuibles a los tipos 16 y 18.



de células exfoliadas de la zona de transformación del cuello uterino. La implantación de programas rutinarios de cribado citológico del cuello uterino ha sido decisiva para reducir significativamente la incidencia y la mortalidad asociadas al cáncer de cuello uterino. Las directrices actuales recomiendan iniciar el cribado a los 21 años y continuar a intervalos regulares, con ajustes basados en la edad de la paciente,



los antecedentes y las pruebas concurrentes de los tipos de virus del papiloma humano de alto riesgo (VPHr). La prueba de Papanicolaou sigue siendo la piedra angular de la atención preventiva ginecológica y un componente fundamental de las estrategias de salud pública encaminadas a controlar el cáncer cervicouterino.
La vacunación contra el VPH es una medida crucial para prevenir las infecciones causadas por los papilomavirus mortales (VPH), un grupo de más de 200 serotipos asociados. Más de 40 de estos tipos se transmiten a través del contacto sexual directo, y algunos de ellos dan lugar a tumores genitales y otros tipos de cáncer, como los de cuello de útero, ano, orofaringe, pene, vulva y vagina. Las vacunas protegen contra los tipos de VPH más peligrosos que provocan la mayoría de estos cánceres, en concreto los tipos 16 y 18, responsables de aproximadamente el 70 % de los cánceres de cuello de útero, y los tipos 31, 33, 45, 52 y 58, responsables de entre el 10 y el 20 % de los cánceres de cuello de útero. Las vacunas contra el VPH también combaten la infección
por los tipos 6 y 11, que originan el 90 % de las verrugas genitales. La vacuna contra el VPH es más eficaz cuando se administra antes del inicio de las relaciones sexuales, por lo que se recomienda la vacunación sistemática de los preadolescentes y adolescentes a los 11 o 12 años, y puede iniciarse a partir de los 9 años. También se recomienda la vacunación a todas las personas hasta los 26 años que no hayan sido vacunadas adecuadamente con anterioridad.
Los estudios de seguimiento a largo plazo han demostrado la seguridad, inmunogenicidad y eficacia sostenidas de la vacuna, y se ha demostrado que se ha producido un descenso poblacional de la frecuencia del VPH, la displasia cervical y las verrugas genitales


en las cohortes vacunadas. En Estados Unidos se han certificado tres vacunas Gardasil, Cervarix y Gardasil 9, siendo la última la única vacuna utilizada desde 2016.
El tratamiento del cáncer de cuello uterino depende del estadio de la enfermedad, la histología del tumor y factores específicos de la paciente, como la edad, los deseos de fertilidad y el estado funcional. La enfermedad en estadio temprano (estadios FIGO IA1-IB1) suele tratarse con opciones quirúrgicas, como la conización, la histerectomía simple o radical y la evaluación de los ganglios linfáticos. La traquelectomía radical, una cirugía para preservar la fertilidad, puede considerarse para pacientes seleccionadas con tumores pequeños, localizados y sin invasión del espacio linfovascular.
Para el cáncer de cuello uterino localmente avanzado (estadios IB2-IVA), la quimiorradioterapia concurrente (CCRT) sigue siendo la piedra angular del tratamiento. Este régimen combina la radioterapia de haz externo (RHE) con la braquiterapia intracavitaria y la quimioterapia basada en cisplatino, que han demostrado mejorar el control local y la supervivencia global. La quimiorradiación también se emplea para tratar la afectación de los ganglios linfáticos pélvicos.
En los casos de cáncer de cuello uterino metastásico o recidivante (estadio IVB), la terapia sistémica es el pilar del tratamiento. Suele emplearse quimioterapia basada en platino, a la que se

añade bevacizumab, un agente antiangiogénico que ha demostrado prolongar la supervivencia en casos metastásicos o recidivantes. Recientemente, los inhibidores del punto de control inmunitario, como el pembrolizumab, han demostrado su eficacia en pacientes con tumores PD-L1 positivos, ofreciendo una prometedora opción de tratamiento para la enfermedad recurrente o metastásica.
Además de las terapias sistémicas y locales, los cuidados paliativos son esenciales para que los pacientes con enfermedad avanzada controlen los síntomas, mejoren su calidad de vida y reciban apoyo psicológico. La investigación en curso se centra en mejorar la eficacia y seguridad de los tratamientos.
El cáncer de cuello de útero sigue siendo un importante problema sanitario mundial, y la prevención mediante la vacunación y la detección precoz a través de cribados periódicos son componentes cruciales para reducir la incidencia y la mortalidad. Los avances en el tratamiento, incluida la quimiorradioterapia para la enfermedad localmente avanzada y las terapias sistémicas para los casos metastásicos, han mejorado significativamente los resultados de supervivencia. Sin embargo, sigue habiendo problemas en el tratamiento de la enfermedad recurrente o resistente, lo que pone de relieve la necesidad de seguir investigando en nuevas estrategias terapéuticas, como la inmunoterapia y los tratamientos dirigidos.
La continuación de los esfuerzos por aumentar la cobertura de vacunación, el acceso al cribado y el tratamiento equitativo será esencial para seguir reduciendo la carga del cáncer cervicouterino en todo el mundo. El objetivo de la Organización Mundial

Dr. José Ángel García Fernández
SEGO SDGO ASRM ESRHE FACOG
Ginecólogo-Obstetra
- Especialista en Reproducción Asistida
de la Salud de eliminar el cáncer cervicouterino como problema de salud pública subraya la importancia de la colaboración y la innovación mundiales en los esfuerzos de prevención y tratamiento.







¡El cuidado natural para tu familia!







• EXPECTORANTE
• MUCOLÍTICO
• BRONCOESPASMOLÍTICO
Congestión de las vías respiratorias con exceso de mucosidad.
Tratamiento sintomático de las afecciones bronquiales.
Facilita la expulsión del moco en niños a partir de los dos años y en adultos.



